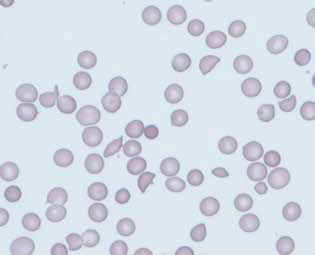
図1

専門医制度
日腎誌特集号関連領域専門医レベル セルフトレーニング問題
学会員の生涯学習や腎専門医取得に際する学習の一環として、日本腎臓学会学会誌の特集号に関連問題を掲載し、解答と解説はホームページにて公表することになりました。
教育・専門医制度委員会
正しいのはどれか。1つ選べ。
| a | アテローマ硬化型石灰化は特にCKDに特徴的な石灰化である。 |
| b | メンケベルグ型石灰化は血管内皮細胞が骨芽細胞様細胞に形質転換することにより進行していく。 |
| c | 冠動脈血流は拡張期に主に流れる。 |
| d | ランダム化比較試験によりスタチンの弁石灰化抑制効果が示されている。 |
| e | 25(OH)Vit.Dは腎臓および腸管からのリンの再吸収を増加させる。 |
問題2.
慢性腎臓病患者におけるミネラル代謝異常でリン利尿作用を有するのはどれか。2つ選べ。
| a | 副甲状腺ホルモン(PTH) |
| b | fibroblast growth factor 23 (FGF23) |
| c | カルシウム |
| d | 25-水酸化ビタミンD |
| e | 活性型ビタミンD(1,25(OH)2D) |
問題3.
CKD-MBDの管理に関して正しいのはどれか。1つ選べ。
| a | 軽度の高Ca血症は生命予後への寄与度から許容される。 |
| b | カルシウム受容体作動薬は、血清カルシウム濃度を低下させる。 |
| c | リン吸着薬の投与は血清リン濃度に関わらず推奨される。 |
| d | 保存期CKDの高リン血症に対する治療の基本はカルシウム含有リン吸着薬である。 |
| e | リンの管理は、厳密なたんぱく制限で達成すべきである。 |
問題4.
68歳、男性。血液透析期間:7年。透析液カルシウム3.0mEq/L, 血清カルシウム10.0mg/dL, リン6.4mg/dL, intact PTH 160pg/mL, アルブミン3.0g/dL。内服薬:アルファカルシドール 0.25μg/日、炭酸ランタン 750mg/日。
この症例の慢性腎臓病に伴う骨ミネラル代謝異常に対する治療方針で正しい組み合わせはどれか。
| 1) | 骨生検で組織を診断したのち決定する。 |
| 2) | アルファカルシドールを増量する。 |
| 3) | 炭酸カルシウムを開始する。 |
| 4) | 透析液カルシウム濃度を低下させる。 |
| 5) | 炭酸ランタンを増量する。 |
a(1.2)、b(1.5)、c(2.3)、d(3.4)、e(4.5)
問題5.
二次性副甲状腺機能亢進症に関して正しいのはどれか。2つ選べ。
| a | 保存期CKD患者のPTH値はシナカルセト塩酸塩を用いて管理する。 |
| b | エテルカルセチド塩酸塩は新たな経口カルシウム受容体作動薬である。 |
| c | カルシウム受容体作動薬は透析患者において血清リン値を低下させる。 |
| d | 欧米ではわが国と比較し、より積極的なPTH降下療法が行われている。 |
| e | 副甲状腺摘出術の手術件数は近年低下傾向にある。 |
問題6.
間違っているのはどれか。1つ選べ。
| a | CKD患者ではFGF23はそのアッセイ方法にかかわらず腎予後を予測する。 |
| b | 保存期においてクエン酸第二鉄の投与はintact FGF23を低下させる。 |
| c | 人種によって骨のPTH感受性は違う。 |
| d | 日本のCKD-MBDガイドライン(慢性腎臓病に伴う骨・ミネラル代謝異常の診療ガイドライン)では、透析患者におけるintact PTH目標値は KDIGOガイドラインのそれより高い。 |
| e | KDIGOガイドラインでは、保存期や腎移植後のPTHの管理上、25(OH)Dの測定が推奨されている。 |
痛風や糖尿病性腎症との関連が指摘されているインフラマソームはどれか.1つ選べ.
| a | NLRP1 |
| b | NLRP3 |
| c | NLRC4 |
| d | AIM2 |
| e | NLRP6 |
問題2.
糖尿病の既往のない患者に実施した腎生検で以下の糸球体病変がみられた。鑑別診断に有用でないのはどれか。1つ選べ。
| a | タンパク尿量 |
| b | 喫煙歴 |
| c | 蛍光抗体法 |
| d | 電子顕微鏡所見 |
| e | 尿中ベンスジョーンズ蛋白 |

問題3.
C3腎症について最も適切と思われる組み合わせはどれか。
| 1 | 低C3血症と低C4血症を伴うことが一般的である。 |
| 2 | 腎病理は膜性増殖性糸球体腎炎像を示す。 |
| 3 | 補体制御因子の遺伝子異常を伴うことがある。 |
| 4 | 診断は腎生検蛍光抗体法所見(IF)が現時点では最も重要である。 |
| 5 | エクリツマブは治療の第一選択に投与される。 |
a(1.2)、b(1.5)、c(2.3)、d(3.4)、e(4.5)
問題4.
以下の文章のうち、正しいものの組み合わせを選べ。
| 1 | SGLT2阻害薬を服用すると、空腹時の血中ケトン体濃度が上昇する。 |
| 2 | SGLT2阻害薬は、その血糖降下作用のために心血管疾患関連死を抑制する。 |
| 3 | 糖尿病性腎症ではミトコンドリアの形態は分裂(fission)から融合(fusion)に傾く。 |
| 4 | マイクロRNA(miRNA)は通常一つの標的遺伝子の発現あるいは翻訳を抑制する。 |
| 5 | ポドサイトや尿細管のオートファジーは糖尿病性腎症において腎保護的に機能する。 |
a(1.2)、b(1.5)、c(2.3)、e(3.4)、e(4.5)
急性腎障害(Acute kidney injury; AKI)について正しいのはどれか。
| a | 7日以内に血清クレアチニン値が基礎値の2.5倍に上昇した場合にKDIGOの診断基準ではAKIステージ2と診断される。 |
| b | 血清クレアチニン値と尿中NGALは同時期に上昇する。 |
| c | 低用量のドパミンにはAKIの予防効果がある。 |
| d | 敗血症にAKIを合併することは少ない。 |
| e | AKI症例はCKDに進展することはほとんどない。 |
問題2.
IgA腎症において腎予後不良因子として不適当なのはどれか。
| a | 不十分な血圧管理 |
| b | 蛋白尿の程度 |
| c | 肉眼的血尿 |
| d | 血清補体価 |
| e | 診断時の血清クレアチニン値の上昇 |
問題3.
15歳の女性.生来健康であった.2日前より腹痛があり近医を受診.精査のために施行された腹部超音波検査で両側の腎臓に2個ずつ直径1cm程度の嚢胞を認めた.両親は健康であるため,特に通院や検査などは受けたことがないが,母方の祖母が40代にくも膜下出血で死亡している.
本例の診断根拠と診断を示す。正しいのはどれか.
| a | 家族歴がなく嚢胞が両腎に2個ずつしかないため,常染色体優性多発性嚢胞腎(ADPKD)とは診断しない. |
| b | 家族歴はないが嚢胞が両腎に2個ずつあるため,ADPKDと診断する. |
| c | 祖母がくも膜下出血の既往があるため,ADPKDの家族歴がある可能性があるが,嚢胞が両腎に2個ずつしかないため,ADPKDとは診断しない. |
| d | 祖母がくも膜下出血の既往があるため,ADPKDの家族歴がある可能性があり,嚢胞が両腎に2個ずつあるため,ADPKDと診断する. |
| e | 祖母がくも膜下出血の既往があるため,ADPKDの家族歴がある可能性があるが,嚢胞が両腎に2個ずつしかないため,現時点ではADPKDと診断できない. |
問題4.
ループス腎炎の寛解導入療法の治療効果をみる臨床試験において,主要エンドポイントの設定に利用されることの多い項目はどれか。
| 1. | 血清Cr値 |
| 2. | 尿蛋白量 |
| 3. | 尿沈渣 |
| 4. | 血清補体価 |
| 5. | 抗dsDNA抗体価 |
a(1.2.3)、b(1.2.5)、c(1.4.5)、d(2.3.4)、e(3.4.5)
ネフローゼ症候群の移行期医療について誤っているのはどれか。1つ選べ。
| a | 小児期発症の微小変化型ネフローゼ症候群の90%は思春期以降に自然寛解する。 |
| b | 十分な説明を受けず移行した患者はステロイドの使用法の違いに不安を抱く。 |
| c | 小児期のネフローゼ症候群の治療ではステロイドによる成長障害(低身長)を防ぐために免疫抑制薬を積極的に併用する。 |
| d | 平成27(2015)年7月に成人に対する医療費助成制度が充実しネフローゼ症候群が指定難病に追加された。 |
| e | 平成22(2010)年に行われたわが国の調査では,ネフローゼ症候群に関する移行プログラムを有する施設はなく,2施設で移行コーディネーターが配置されているのみであった。 |
問題2.
3歳の女児。血便を主訴に入院。7日前に家族で焼き肉を摂取した。3日前から血液が混入した。下痢を頻回に認め近医を受診した。 急性胃腸炎として補液を受けたが,血便が持続するため紹介入院となった。 入院時の血液検査所見:白血球22,400/μL,Hb 9.0 g/dL,血小板4.4 万/μL,血清クレアチニン0.56 mg/dL。 末梢血塗抹像を図に示す。この患者の血液検査所見で誤った事項はどれか。1つ選べ。
| a | LDHの上昇 |
| b | ビリルビンの上昇 |
| c | ハプトグロビンの低下 |
| d | クームス試験陽性 |
| e | CRPの上昇 |
問題3.
移行期医療について正しいのはどれか。1つ選べ。
| a | 先天性腎尿路異常(CAKUT)の成人期では一律塩分を6 g/日未満に制限する。 |
| b | 移行プログラムは医師による詳細な紹介状作成で完了する。 |
| c | 小児発症ネフローゼ症候群の成人期治療では小児期に実施されたステロイド投与法を踏襲する。 |
| d | 小児発症IgA 腎症の非寛解例では移行期において口蓋扁桃摘出およびステロイドパルス併用療法は治療選択の1つとなりうる。 |
| e | 小児発症ループス腎炎(class Ⅲ or Ⅳ)の女性では、ステロイド+シクロホスファミド併用療法がステロイド+ミコフェノール酸モフェチル併用療法よりも寛解導入率が有意に高い。 |
臨床試験と証明された結果との関係で正しいのはどれか。1つ選べ。
| a | RASS - ロサルタンによる微量アルブミン発症抑制効果 |
| b | VA NEPHRON-D - ACE阻害薬とARBによる相乗腎保護効果 |
| c | Kumamoto Study - 厳格血糖管理による総死亡抑制 |
| d | ADVANCE - 厳格血糖管理による末期腎不全進行抑制 |
| e | ALTITUDE - トルバプタンによる心不全抑制 |
問題2.
正しいのはどれか。2つ選べ。
| a | GLP-1受容体作動薬はインスリンとグルカゴンの分泌を促進する。 |
| b | GLP-1受容体作動薬は体重を減少させる。 |
| c | GLP-1受容体作動薬は降圧作用を示す。 |
| d | GLP-1受容体作動薬は血管収縮作用を示す。 |
| e | GLP-1受容体作動薬はAMP kinase活性を抑制する。 |
問題3.
糖尿病性腎臓病におけるアルドステロン拮抗薬について誤っているのはどれか。1つ選べ。
| a | 高血圧症の場合にはエプレレノンを微量アルブミン尿または蛋白尿を伴う糖尿病患者に投与することは禁忌である。 |
| b | アルドステロン拮抗薬は、糖尿病性腎臓病でのアルブミン尿の減少効果が期待できる。 |
| c | エプレレノンは、心不全を合併しない糖尿病性腎臓病における心不全予防効果がある。 |
| d | スピロノラクトンは、慢性心不全への保険適用がない。 |
| e | アルドステロン拮抗薬を投与する際には、RA系阻害薬など併用薬への注意が必要である。 |
問題4.
正しいのはどれか。
1. Nrf2は酸化ストレス応答にかかわる転写因子である。
2. 酸化ストレス存在下にNrf2の転写が低下する。
3. バルドキソロンメチルはNrf2の分解を促進する。
4. 糖尿病性腎臓病患者に対するバルドキソロンメチル投与で糸球体濾過量が低下する。
5. バルドキソロンメチルの副作用として心不全の報告がある。
| a | (1.2) |
| b | (1.5) |
| c | (2.3) |
| d | (3.4) |
| e | (4.5) |
問題5.
正しいのはどれか。
1. 慢性炎症状態では生体内におけるエリスロポエチン(EPO)遺伝子発現が高まる。
2. PHD阻害薬は低酸素誘導因子(HIF)を安定化させる。
3. PHD阻害薬は経口内服可能な小分子化合物である。
4. PHD阻害薬による赤血球造血の主な作用部位は尿細管上皮細胞である。
5. PHD阻害薬による腎性貧血治療は、血清ヘプシジン値を上昇させる。
| a | (1.2) |
| b | (1.5) |
| c | (2.3) |
| d | (3.4) |
| e | (4.5) |
問題6.
16歳の男性。H因子遺伝子変異による非典型溶血性尿毒症症候群の治療のために、6年前から2週間に1回のエクリズマブ投与を受けている。本日起床時に倦怠感と頭痛を認め体温は38.3℃であった。学校ではインフルエンザウイルス感染が流行しており、昨日もクラスメイト4名が欠席したという。その後体温が39度台になり、四肢の痛みと悪寒戦慄が出現し、頭痛も強くなってきたために、同日14時に救急外来を受診した。
外来受診時身体所見:意識清明だがぐったりしている。末梢冷感は認めない。体温39.2℃、脈拍120回/分、血圧130/82、呼吸数22回/分。血液検査:WBC 12,800、Hb 16.3 g/dL、血小板15万、LDH 280 IU/L、クレアチニン 0.9 mg/dL、CRP 1.8 mg/dL。インフルエンザウイルス迅速テスト陰性。エクリズマブは10日前に投与されている。
次のうち最も適切な対応はどれか。
| a | 一旦帰宅させインフルエンザ迅速テスト再検査のために翌日の再受診を指示 |
| b | 等張電解質輸液 |
| c | ペラミビル投与 |
| d | セフトリアキソン投与 |
| e | エクリズマブ投与 |
問題7.
免疫抑制薬と治療上の標的となる分子の組み合わせで、正しいものはどれか。
1.アザチオプリン - Nudix Hydrolase 15(NUDT15)
2.ミコフェノール酸モフェチル - イノシン1リン酸デヒドロゲナーゼ(IMPDH)
3.ベリムマブ - Bリンパ球刺激因子 (BLyS)
4.ミゾリビン - チオプリンS-メチルトランスフェラーゼ(TPMT)
5.リツキシマブ - CD4
| a | (1.2) |
| b | (1.5) |
| c | (2.3) |
| d | (3.4) |
| e | (4.5) |
誤りはどれか。1つ選べ。
| a | 糖新生は肝臓約75%、腎臓約25%の比率で通常行われる。 |
| b | 腎皮質では脂肪酸が主要エネルギー源であるのに対し、腎髄質では糖を主に利用する。 |
| c | 原尿中の糖は約90%がSGLT1を介して再吸収される。 |
| d | 糖尿病では腎臓での糖取り込みが増加している。 |
| e | 家族性腎性糖尿病はSGLT2遺伝子の変異に起因する。 |
問題2.
食事で摂取するたんぱく質について、正しいのはどれか。1つ選べ。
| a | 一般的に植物性たんぱく質は動物性たんぱく質より消化性必須アミノ酸スコア(digestible indispensable amino acid score:DIAAS)が高い。 |
| b | 腎予備能が保たれている場合、たんぱく質を摂取すると食品により程度の異なる一過性の糸球体過剰濾過(hyperfiltration:HF)を生じる。 |
| c | 植物性たんぱく質はリン含有量が多く、消化管からの吸収率も高い。 |
| d | 食事による外因性の終末糖化産物(advanced glycation end products:AGEs)は、焼く、揚げるなど高温で乾燥した加熱調理法で生じにくい。 |
| e | DASH食(Dietary Approaches to Stop Hypertension diet)とは,果物・野菜を多く摂取し、飽和脂肪酸が少なく、オリーブオイルが多い地中海沿岸諸国の伝統的な食事パターンのことである。 |
問題3.
正しいのはどれか。2つ選べ。
| a | CKD患者において食塩摂取量は尿蛋白量と関連が無い。 |
| b | 現在、最も信頼できる食塩摂取量評価法は24時間蓄尿である。 |
| c | Tanakaの式で食塩摂取量評価をする場合は起床後第2尿を用いなければいけない。 |
| d | 食塩摂取の管理により、心血管疾患の発症を抑制できる可能性がある。 |
| e | 高齢CKD患者には食塩摂取制限を行う必要がない。 |
問題4.
CKD-MBDにおける栄養管理に関して正しいのはどれか。1つ選べ。
| a | たんぱく質制限は制限するほど生命予後に良い影響を与える。 |
| b | 有機リンと無機リンでは有機リンの方が腸管から吸収されやすい。 |
| c | CKD進行に伴って顕在化する低カルシウム血症に対しては、積極的にカルシウム製剤を使用して基準値内に維持することが推奨される。 |
| d | 腎不全ではマグネシウム製剤は一切使用せず、血清マグネシウム濃度は低ければ低く保たれるほど良い。 |
| e | 透析患者では食事によるリン制限を徹底するだけでは良好な生命予後がえられない。 |
問題5.
CKD患者のエネルギー摂取量について誤りはどれか。1つ選べ。
| a | エネルギー投与量を決定するためには総エネルギー消費量を決定する必要がある |
| b | 基礎(安静時)エネルギー消費量の推定法として、間接カロリメーターによる測定が有用である |
| c | Harris-Benedict式などから算出した基礎(安静時)エネルギー消費量は、実測値との間に乖離がある |
| d | 保存期CKD患者の基礎(安静時)エネルギー消費量は亢進している |
| e | 透析期CKD患者の目標エネルギー摂取量は30~35 kcal/kg 標準体重/日である |
問題6.
透析患者の栄養状態の特徴として正しいのはどれか。1つ選べ。
| a | 血清アルブミン値の測定法はBCG法に全国的に統一されている。 |
| b | 血液透析では、ダイアライザーからアルブミンが透析液中に失われることはない。 |
| c | 透析患者に低アルブミン血症を認めた場合、低栄養を表しているので高エネルギー・高たんぱく質食をまず与える。 |
| d | 透析患者のprotein energy wastingには炎症が関与しているため、診断基準に心血管疾患の既往歴とC反応性蛋白が含まれている。 |
| e | 高齢血液透析患者のたんぱく質摂取量は若年血液透析患者よりも少ない傾向がある。 |
28歳の男性。腹部膨満感と発熱を主訴に来院した。3年前に高血圧を指摘されたが降圧薬は内服していない。母親が慢性腎不全で60歳から血液透析を受け、65歳時にくも膜下出血で死亡している。
身体所見:体温38.2℃。血圧162/90 mmHg。腸蠕動音は弱い。腹部触診で両側の腹部に凹凸のある腫瘤を触れる。左背部に鈍痛あり。尿所見:蛋白 +、糖(-)、潜血(±)、沈渣白血球>100/視野。血液検査所見:WBC 16,200, 赤血球382万、Hb 10.2 g/dl, 血小板28万。血液生化学所見:アルブミン3.8 g/dL、尿素窒素22 mg/dL、クレアチニン1.2 mg/dL、CRP 12.9 mg/dL。
この疾患で正しいのはどれか。1つ選べ。
| a | ニューキノロン系の抗菌薬が第一選択である。 |
| b | 起因菌はグラム陽性球菌が多い。 |
| c | ドレナージが第一選択である。 |
| d | 診断にはPET-CTが第一選択である。 |
| e | 感染症はこの疾患の死亡原因の第1位である。 |
問題2.
51歳の女性。生来健康であったが、人間ドックの超音波検査で腎嚢胞を指摘されたため来院した。患者は23歳頃から毎年健診を受診していたが、異常は指摘されていなかった。身体所見では血圧 149/86 mmHg.入院時の血液検査では、Hb 12.6 g/dL,クレアチニン 1.3 mg/dLであった。腎疾患の家族歴を認めない。
本例の診断を行ううえで、次に行うべき検査はどれか。
| a | 腎生検 |
| b | 頭部MRA |
| c | 腹部単純CT |
| d | 遺伝子診断 |
| e | イヌリンクリアランス |
問題3.
遺伝性嚢胞性腎疾患と責任遺伝子の組み合わせて誤っているのはどれか。
| a | 常染色体優性多発性嚢胞腎 - PKD1 |
| b | 常染色体劣性多発性嚢胞腎 - NPHP1 |
| c | ネフロン癆 - NPHP3 |
| d | 常染色体優性尿細管間質性腎疾患 - UMOD |
| e | ジュベール症候群 - CEP290 |
問題4.
常染色体劣性多発性嚢胞腎(ARPKD)について正しいのはどれか。1つ選べ。
| a | いかなる年齢においても診断しうる。 |
| b | 男児に多い。 |
| c | 診断に遺伝子解析が必須である。 |
| d | 近位尿細管の拡張が腎の主病変である。 |
| e | 肝細胞が肝病変の首座である。 |
問題5.
18歳の女性。生来健康。感冒で近医を受診した際に腎機能障害(eGFR 35mL/min/1.73m2)を指摘され当科紹介となった。
家族歴:25歳の兄が腎機能障害からネフロン癆と診断され、20歳から血液透析を施行されている。
本例について正しいのはどれか.1つ選べ。
| a | NPHP1の異常によるものが多い。 |
| b | リツキシマブの投与が有効である。 |
| c | 本患者の子に50%の確率で遺伝する。 |
| d | 学校検尿で尿蛋白陽性となることが多い。 |
| e | 腎生検で糸球体基底膜の肥厚が見られる。 |
問題6.
常染色体優性遺伝性間質尿細管腎症(ADTKD)に関して正しいのはどれか。
1. ADTKDの病理組織所見は間質の線維化及び尿細管基底膜の不整など、非特異的である。
2. ADTKD-UMODでは早期から尿酸値の上昇が認められる。
3. ADTKD-MUC1の遺伝子解析は困難な場合がある。
4. ADTKDでは検尿異常が全面に現れることが多い。
5. ADTKDでは腎臓の萎縮が早期から認められる。
| a | (1.2.3) |
| b | (1.2.5) |
| c | (1.4.5) |
| d | (2.3.4) |
| e | (3.4.5.) |
52歳の女性。幼少期から尿蛋白を指摘されており,20年前に右腎の萎縮を指摘された。7年前に高血圧と血清Cr 1.74mg/dLの腎機能障害を指摘。2年前にBUN 82.2mg/dL,Cr 4.93mg/dLまで腎機能増悪を認めたため,左前腕内シャント造設術を施行した。その後,徐々に腎機能は増悪し,Cr 8.83mg/dLまで上昇したため,1年前に血液透析開始となった。その後,弟をドナーとする生体腎移植を希望され外来受診し,血液型不適合(B+ → A+)およびDSA陽性(HLA 5 mismatch,DSA ClassⅠ陽性)に対し術前の脱感作療法を施行した。脱感作療法の内容として適切でないのはどれか。1つ選べ。
| a | rituximab |
| b | ステロイド薬 |
| c | タクロリムス |
| d | ミコフェノール酸モフェチル |
| e | エタネルセプト |
問題2.
近年のエビデンスに基づいた糖尿病性腎臓病(DKD)の腎予後バイオマーカーと,それが反映する腎病理組織学的変化の組み合わせで誤っているのはどれか。1つ選べ。
| a | 血漿KIM-1 - 尿細管間質障害 |
| b | 血清TNFR2 - 糸球体内皮細胞fenestrationの減少 |
| c | IgG4/IgG クリアランス比 - 糸球体基底膜におけるチャージバリアの破綻 |
| d | 血漿TNFR1 - メサンギウム基質増加 |
| e | 尿中MCP-1 - 細動脈硝子化 |
問題3.
代謝について正しいのはどれか。
| a | トリプトファンは主に腎臓で代謝される。 |
| b | ミトコンドリア外膜はイオンや小分子を通過させない。 |
| c | トリプトファンは腸内細菌によりフェニル硫酸に代謝される。 |
| d | シトクロムcはミトコンドリア外膜に存在する電子伝達系の蛋白質である。 |
| e | アシルCoAはカルニチンと結合しアシルカルニチンとなりミトコンドリア内膜を通過する。 |
問題4.
糖尿病患者を対象に,SGLT2阻害薬による腎イベント抑制効果を「主要評価項目」として検証した昨今の大規模臨床研究の結果をもとに,SGLT2阻害薬により腎予後の改善が期待できる糖尿病性腎臓病(DKD)の病態はどれか。1つ選べ。(ただし,eGFRはCKD-EPI式での値とする。)
| a | 1型糖尿病,尿中アルブミン排泄量1,000mg/gCr,eGFR 55mL/分/1.73m2 |
| b | 2型糖尿病,尿中アルブミン排泄量2,000mg/gCr,eGFR 40mL/分/1.73m2 |
| c | 2型糖尿病,尿中アルブミン排泄量7,500mg/gCr,eGFR 55mL/分/1.73m2 |
| d | 2型糖尿病,尿中アルブミン排泄量150mg/gCr,eGFR 35mL/分/1.73m2 |
| e | 2型糖尿病,尿中アルブミン排泄量2,500mg/gCr,eGFR 15mL/分/1.73m2 |
問題5.
SGLT2阻害薬に関連する事項を示す。誤りはどれか。2つ選べ。
| a | SGLT2は遠位尿細管に存在し,そこに流入した糖はNa+とともに再吸収される。 |
| b | SGLT2阻害薬は糖尿病性腎症における糸球体過剰濾過や糸球体高血圧を是正することが, 腎保護効果を示すメカニズムの1つであると考えられている。 |
| c | 進行した糖尿病性腎症の症例ほどSGLT2阻害薬による腎保護効果は早期に認められる。 |
| d | SGLT2阻害薬はケトアシドーシスを助長する可能性がある。 |
| e | SGLT2阻害薬の副作用として心不全に注意する必要がある。 |
問題6.
糖尿病例における腎病理所見に関する記載で正しいのはどれか。1つ選べ。
| a | 結節性病変の出現は腎予後不良を示唆する。 |
| b | アルブミン尿陰性の症例では病理学的変化は見られない。 |
| c | 糸球体肥大は糖尿病による病理所見として特異性が高い病変である。 |
| d | アルブミン尿の程度とeGFRの程度が同等であれば病理所見も類似する。 |
| e | 長期糖尿病歴があり網膜症があれば糖尿病以外の腎病変は見られない。 |
問題7.
糖尿病性腎臓病(DKD)および糖尿病性腎症に関する次の記述のうち誤っているのはどれか。2つ選べ。
| a | DKDは従来の典型的な糖尿病性腎症の経過とは異なり,顕性アルブミン尿を伴わないままGFRの低下を示す症例の総称である。 |
| b | DKDの早期発見のためには,アルブミン尿が陰性の症例であっても腎機能の推移を慎重に見る必要がある。 |
| c | DKDの進展抑制のためには,血糖管理に加えて食事・運動療法を中心に禁煙や口腔ケアを含む生活習慣の改善,血圧・脂質・肥満の集学的治療が重要である。 |
| d | 糖尿病性腎症患者においてHbA1c 7.0%未満の血糖管理は早期腎症から顕性腎症への進行を抑制し,顕性腎症以降の進行期においても末期腎不全への進行抑制や心血管疾患(CVD)発症率を下げる。 |
| e | 糖尿病性腎症の治療について,GLP-1作動薬やSGLT2阻害薬の有用性が近年示されている。 |
移植後早期に再発し,腎機能廃絶に落ち入りやすい疾患はどれか。2つ選べ。
| a | IgA腎症 |
| b | 膜性腎症 |
| c | ループス腎炎 |
| d | リポ蛋白糸球体症 |
| e | 巣状分節性糸球体硬化症 |
問題2.
32 歳の女性。IgA 腎症を原疾患とする進行性の慢性腎臓病に対して,担当医があと1年未満での透析導入見込みと判断し,腎代替療法選択のため紹介となった。既往歴に特記すべき事項なし。妊娠出産歴はない。
理学的所見:身長156cm,体重42kg,下肢浮腫なし。
一般臨床検査:尿検査;潜血 2+,尿蛋白 2+,1 日尿蛋白定量 1.2g/日。血液検査;血清クレアチニン4.2mg/dL,eGFR 11.0mL/分/1.73m2,血清アルブミン3.6g/dL。
腎代替療法の療法選択提示を行ったところ,腎移植を希望した。家族会議にて相談したところ,生体腎移植ドナーとして以下の5名が考慮された。わが国で生体腎移植ドナーとして適格なのはどれか。2つ選べ。
| a | 29歳の妹。既婚。eGFR 95mL/分/1.73m2, 検尿異常なし。 本人に提供の意思はあるが,夫は提供に反対している。 |
| b | 62歳の父。HbA1c 7.0%(インスリン治療中)。eGFR 90mL/分/1.72m2, 尿アルブミン定量 33mg/g クレアチニン。強い提供の希望あり。 |
| c | 65歳の叔父(父の兄)。eGFR 82mL/分/1.72m2。6年前に早期胃癌に対して内視鏡的粘膜切除術を施行,その後再発なし。自発的な提供の意思あり。 |
| d | 71歳の夫の母。血圧 122/75mmHg。eGFR 79mL/分/1.73m2, 尿アルブミン定量 20mg/g クレアチニン,降圧薬としてカルシウム拮抗薬を1剤内服中。自発的な提供の意思あり。 |
| e | 33歳の女性。小学校の時からの親友。eGFR 92mL/分/1.72m2,検尿異常なし。自発的な提供の意思あり。 |
問題3.
腎移植とエピトープ解析に関する次の記述のうち誤りはどれか。2つ選べ。
| a | エピトープは機能的エピトープと構造的エピトープに分類され,このなかで機能的エピトープはエプレットと呼ばれる。 |
| b | ドナーとレシピエント間におけるエプレットのミスマッチが多いと新規ドナー特異的抗体の発生頻度は低下する。 |
| c | エプレット解析はドナー,レシピエントの4桁HLAアレル情報が必須である。 |
| d | 新規ドナー特異的抗体の発生について,HLA-DQ抗原におけるミスマッチが最も強く関与している。 |
| e | 1つのエプレットに1種類の抗HLA抗体が反応する。 |
問題4.
腎移植後に起こる血栓性微小血管症(thrombotic microangiopathy:TMA)に関する次の記述のうち誤りはどれか。2つ選べ。
| a | 腎移植後のTMAについて,統一された診断基準が存在する。 |
| b | ABO血液型不適合腎移植はTMAのリスク因子である。 |
| c | 腎移植直後に起こる血小板減少や溶血性貧血所見を伴ったTMAは,病因が確定した後に治療を行うべきである。 |
| d | 腎移植後のTMAは,溶血性尿毒症症候群(HUS)などの再発性TMAよりもde novo TMAのほうが多い。 |
| e | 腎移植後のTMAの原因が明確にならないことが多い。 |
問題5.
腎移植後の日和見ウイルス感染症のリスクを評価するうえで正しいのはどれか。2つ選べ。
| a | 感染症のリスク評価は腎移植が終了し患者の病状が落ち着いてから行う。 |
| b | EBV(Epstein-Barr virus)による,移植後リンパ増殖性疾患などの合併症は小児よりも成人で多く見られる。 |
| c | 腎移植レシピエントにおける,BKPyV(BK polyoma virus)腎症の予防法として,血漿BKPyV DNA量のモニタリングが有効である。 |
| d | 腎移植後におけるCMV(cytomegalovirus)感染症はCMVの再活性化により起こるためレシピエントが既感染の時に最もリスクが高い。 |
| e | 感染症のリスクに応じたモニタリングシステムの導入が患者の予後改善に役立つ。 |
問題6.
腎移植患者で標準化罹患比(standardized incidence ratio:SIR)が上昇する悪性腫瘍はどれか。2つ選べ。
| a | 胃癌 |
| b | 子宮頸癌 |
| c | 腎癌 |
| d | 前立腺癌 |
| e | 非メラノーマ皮膚癌 |
維持血液透析患者の運動療法に関する次の記述のうち誤りはどれか。2つ選べ。
| a | 運動療法は透析患者の運動耐容能やQOLを改善することが複数の無作為化比較試験から明らかにされている。 |
| b | レジスタンス運動は有害事象発生のリスクがあり透析患者では推奨されない。 |
| c | 透析施行中の運動療法は透析前半の時間帯に実施することが推奨されている。 |
| d | 運動処方の際に用いるFITTの原則とは,Frequency(運動頻度),Interval(運動間隔),Time(運動時間)およびType(運動の種目)から構成される。 |
| e | 有酸素運動は運動負荷試験に基づいた運動処方をするか,Borgスコアの11(楽である)~13(ややきつい)を目安に実施することが推奨される。 |
問題2.
診療ガイドラインに関する記載のうち正しいのはどれか。
| a | 診療上の重要度の高い医療行為について,エビデンスのシステマティックレビューとその総体評価,益と害のバランスなどを考量して策定される文書である。 |
| b | 診療ガイドライン通りの治療を行うことは,患者の希望よりも優先されてよい。 |
| c | 少人数の専門家により推奨文の作成と解説を作成することが望まれる。 |
| d | 診療ガイドライン通りの治療方針を実施することがすべての患者の診療の基本となる。 |
| e | 診療ガイドラインで推奨されない治療を行うと法的に処罰を受ける。 |
問題3.
保存期CKD患者の腎臓リハビリテーションに関する記述のうち誤りはどれか。1つ選べ。
| a | 血圧180╱100mmHg 以上の場合は開始しない。 |
| b | 嫌気性代謝閾値(AT)を上回る負荷の有酸素運動を心がける。 |
| c | ゴムバンドを用いたレジスタンス運動は推奨されている。 |
| d | 60秒の静止を伴う柔軟体操を行う。 |
| e | 腎移植患者は保存期CKD患者に対する運動処方を参考にする。 |
問題4.
CKD患者に合併するサルコペニア・フレイルおよび食事療法について正しいのはどれか。1つ選べ。
| a | CKD患者に合併するサルコペニア・フレイルは,たんぱく質制限により発症する。 |
| b | サルコペニア・フレイルがCKD患者に合併する頻度は,CKDの進行(腎機能の低下)とともに増加する。 |
| c | 高齢CKD患者では死亡リスクより末期腎不全リスクのほうが高い。 |
| d | CKDの標準的食事療法とサルコペニア・フレイルの予防や改善の食事療法は,両立できる。 |
| e | CKD患者に合併するサルコペニア・フレイルを治療するためには,たんぱく質摂取量は多いほど有益である。 |
問題5.
サルコペニアと関連性がないのはどれか。
| a | 血清クレアチニン濃度 |
| b | 血清リン濃度 |
| c | 血清ナトリウム濃度 |
| d | 腫瘍壊死因子-α(Tumor Necrosis Factor-α:TNF-α) |
| e | ビタミンD |
問題6.
サルコペニアに関する記述のうち誤りはどれか。1つ選べ。
| a | サルコペニアを合併するCKD患者の生命予後は,合併しないCKD患者よりも不良である。 |
| b | CKDにサルコペニアを合併する頻度はCKDステージの進行とともに増加する。 |
| c | 筋肉量が減少するほど,尿中に排泄されるクレアチニン量も減少する。 |
| d | サルコペニアを合併したCKD患者に対する食事療法として,エネルギー摂取量の制限を行う。 |
| e | CKD患者におけるサルコペニアの発症や進展には,炎症,代謝性アシドーシス,ビタミンD作用の不足,尿毒素蓄積などのさまざまな要因が寄与している。 |
集合管に関する次の記述のうち誤りはどれか。2つ選べ。
| a | 間在細胞は酸塩基平衡の調節にのみ関与する。 |
| b | 集合管は鉱質コルチコイド受容体(MR)拮抗薬の主要な作用部位である。 |
| c | 集合管では糸球体で濾過されたナトリウム総量のうち約2%が再吸収される。 |
| d | 主細胞と間在細胞の分化にはNotchシグナルが関与する。 |
| e | pendrinは主細胞に発現する。 |
問題2.
マグネシウムに関する次の記述のうち誤りはどれか。2つ選べ。
| a | 慢性腎臓病患者に対する酸化マグネシウムの投与は禁忌である。 |
| b | ジギタリス製剤使用中の患者では低マグネシウム血症にも注意が必要である。 |
| c | プロトンポンプ阻害薬は尿中マグネシウム排泄を亢進させる。 |
| d | インスリン抵抗性は尿中マグネシウム排泄を亢進させる |
| e | マグネシウムには血管石灰化抑制効果がある。 |
問題3.
下垂体後葉からのarginine vasopressin(AVP)分泌を最も強力に増加させるのはどれか。1つ選べ。
| a | 口渇 |
| b | 出血性ショック |
| c | 血漿浸透圧の上昇 |
| d | 血漿浸透圧の低下 |
| e | 高ナトリウム血症 |
問題4.
うっ血性心不全の急性増悪時の治療中に,血清クレアチニン濃度の上昇に伴い,経口ループ利尿薬の効果の減弱がみられた。この病態に関与している因子で誤っているのはどれか 2つ選べ。
| a | 高クロール血症 |
| b | 低クロール血症 |
| c | 高カリウム血症 |
| d | 低カリウム血症 |
| e | 低ナトリウム血症 |
問題5.
酸塩基平衡,カリウム代謝に関する次の記述のうち誤りはどれか。2つ選べ。
| a | 高カリウム血症は尿中酸排泄を阻害し,代謝性アシドーシスは尿中カリウム排泄を阻害する。 |
| b | 尿中カリウム排泄,酸排泄はアルドステロンによる調節を受け,それぞれ集合尿細管の主細胞と間在細胞で行われる。 |
| c | CKD患者において,尿中酸排泄量が少ないほど生命予後と腎予後が不良となることが示されている。 |
| d | 「エビデンスに基づくCKD診療ガイドライン2018」では,静脈血ガス分析でHCO3−が18mmol/Lを下回ったらNaHCO3投与を開始することが提案されている。 |
| e | カリウムの摂取量の増加は,塩分感受性高血圧に対しての降圧効果があり,進行したCKD患者においては腎機能の低下や死亡率を抑制する。 |
問題6.
SGLT2阻害薬について正しいのはどれか。2つ選べ。
| a | 2型糖尿病患者に対するSGLT2阻害薬投与により,心不全による入院の危険度は上昇する。 |
| b | 2型糖尿病患者に対するSGLT2阻害薬投与は,ACE阻害薬・ARB内服中の患者では腎保護効果は証明されていない。 |
| c | 糖尿病性腎臓病を有する患者においてもSGLT2阻害薬の腎保護効果は臨床試験で示されている。 |
| d | HFrEF(heart failure with reduced ejection fraction)患者に対するSGLT2阻害薬の心血管イベント抑制効果は2型糖尿病の有無で異なる。 |
| e | 2型糖尿病患者に対するSGLT2阻害薬投与により糖尿病性ケトアシドーシス(DKA)のリスクは上昇する。 |
SGLT2阻害薬について正しいのはどれか。
| a | 腎保護効果は血糖降下作用に依存的である。 |
| b | 非糖尿病患者における心腎保護効果はない。 |
| c | eGFRの初期のdippingは全ての患者に生じる。 |
| d | ケトン体によるmTORC1の低下が腎保護に重要である。 |
| e | エンドポイントに使用されているクレアチニン倍化はeGFR30%の低下と同等である。 |
問題2.
IgG4関連腎臓病の診断に関する記述のうち誤りはどれか。2つ選べ。
| a | 花筵状線維化とよばれる浸潤細胞を取り囲むような特徴的な線維化はIgG4関連腎臓病の病理診断に有用である。 |
| b | 血清IgG4は全例で上昇している。 |
| c | 38度以上の発熱はみられにくい。 |
| d | しばしば末梢血好酸球増多を認めるが3,000╱mm3>を超える場合はむしろ別の疾患を疑う。 |
| e | ANCA関連血管炎とIgG4関連腎臓病はしばしば合併する。 |
問題3.
共同意思決定(Shared Decision Making)に関する以下の記述のうち,不適切なものはどれか。
1. 医師と患者が治療方針などの決定に関して合意に至るコミュニケーションのプロセスである。
2. 決定にあたっては,エビデンスに基づく医学的情報の他に,患者の価値観,選好(preference)を考慮する。
3. 意思決定ガイドは複雑な意思決定を支援するのに役立つ。
4. 患者の自己決定権を保証するために,医師は自らの意見や提案を示さないようにする。
5. インフォームド・コンセントと対立する考え方である。
| a | (1,2) |
| b | (1,5) |
| c | (2,3) |
| d | (3,4) |
| e | (4,5) |
IgA腎症患者の血清で特徴的に認められる抗体はどれか。2つ選べ。
| a | 抗2本鎖DNA 抗体(anti-ds DNA-ab) |
| b | ガラクトース欠損IgA1(Galactose-deficient variants of IgA1:Gd-IgA1) |
| c | 抗Ro自己抗体 |
| d | 抗ガラクトース欠損IgA1自己抗体(anti-Gd-IgA1 autoantibody) |
| e | 抗SS-A/Ro抗体 |
問題2と問題3は連問
問題2.臨床問題
症例:30歳女性,会社員
現病歴:200X年7月,健康診断の尿検査にて尿潜血(±),尿蛋白 3+を指摘され,精査目的に同年10月に腎臓内科外来受診となった。200X-3年の健診から尿潜血(±~1+)を指摘されていたが,尿蛋白を指摘されたことはなかった。200X-3年に泌尿器科で再検査し,尿沈渣で赤血球 10-19/HPF認めたが,泌尿器科的に異常を認めず終診となっていた。今回,外来受診時の尿検査では,尿潜血(-),尿蛋白 3+,尿糖(-),尿沈渣では赤血球 20-29/HPF,尿蛋白 144mg/dL,尿 Cr90mg/dLであった。
本症例において,腎臓内科外来受診時の判断で正しいのはどれか。
| a | 患者は漢方薬を常用している可能性が高い |
| b | 患者はビタミンCを常用している可能性が高い |
| c | 溶血の精査が必要である |
| d | まず,泌尿器科的精密検査が必要である |
| e | 外来時の尿検査時に生理であった可能性が高い |
問題3.臨床問題
精密検査のために入院となった。
既往歴:特記事項なし,入院時現症:身長150cm,体重62kg,血圧152/94mmHg,体温36.3℃,胸腹部所見異常なし,皮膚・関節所見異常なし,浮腫なし
検査所見:WBC 6,600/μL,Hb 13.0g/dL,Plt 21.5×104/μL,TP 7.0g/dL,Alb 4.2g/dL,BUN 14mg/dL,Cr 1.0mg/dL,eGFR 52.6mL/min/1.73m2,HbA1c 6.1%,UA 7.2mg/dL,TG 262mg/dL,LDL 168mg/dL,抗核抗体陰性,ASO 10IU/mL,ASK 128倍,C3 100mg/dL,C4 20mg/dL,CH50 48U/mL,MPO-ANCA 陰性,PR3-ANCA 陰性,抗GBM 抗体陰性
尿沈渣 赤血球 20~29/HPF,蛋白 168mg/dL,尿Cr 84mg/dL
本症例の尿所見異常の原因として最も可能性が高い疾患はどれか。
| a | 膀胱癌 |
| b | IgA血管炎 |
| c | 腎硬化症 |
| d | IgA腎症 |
| e | 溶連菌感染後急性糸球体腎炎 |
問題4.
ループス腎炎の病態と治療に関する次の記述のうち正しいものはどれか。2つ選べ。
| a | ループス腎炎の病態進展にはTh17細胞の関与は少ないとされる。 |
| b | ループス腎炎では腎臓内にも胚中心様構造が見られ,自己抗体を産生する形質細胞が同定されている。 |
| c | 樹状細胞のサブセットのなかでI型IFN産生に関与する細胞は骨髄系樹状細胞である。 |
| d | ループス腎炎ではポドサイトやメサンギウム細胞などの腎局在細胞による免疫応答も病態形成に関与している。 |
| e | B細胞活性化因子(BAFF)は主に形質細胞の生存に関与し,belimumab投与によりIgG型抗体は速やかに低下する。 |
問題5.
免疫チェックポイント阻害薬(ICIs)に関連した腎障害の記述のうち,正しいものはどれか。2つ選べ。
| a | 発症頻度は10%程度である。 |
| b | プロトンポンプ阻害薬は急性間質性腎炎(AIN)の発症リスクを高める。 |
| c | ICIsによるAIN に対してステロイドは短期間で減量・中止する。 |
| d | ICIsによるTMA においてもADAMTS13活性やインヒビター測定は有用である。 |
| e | 腎移植患者において,ICIs投与による拒絶反応は腎予後良好である。 |
KDIGO 2012 clinical practice guideline for the evaluation and management of chronic kidney disease において,CKDのcriteriaに含まれる項目を1つ選べ。
| a | 30mg/gCr以上のアルブミン尿 |
| b | 300mg/gCr以上のアルブミン尿 |
| c | 0.15g/gCr以上の蛋白尿 |
| d | 0.5g/gCr以上の蛋白尿 |
| e | (+1)以上の蛋白尿 |
問題2.
新型コロナウイルス感染症(COVID-19)について正しいものを2つ選べ。
| a | 透析患者におけるファイザー社のmRNAワクチン2回接種1カ月後の抗体獲得率は50%程度と低い。 |
| b | 飛沫感染と接触感染への対策として,物理的な距離をとること,フェイスマスクとアイガードを着用することの効果が,メタアナリシスで確認されている。 |
| c | 環境消毒として,0.1%次亜塩素酸ナトリウムは有効であるが,アルコール系消毒薬の効果は低い。 |
| d | ファイザー社mRNAワクチンの臨床試験では,56歳以上より55歳以下で発熱や倦怠感などの副反応の発生頻度が高かった。 |
| e | 本邦の透析患者での致死率は,一般人口と比較して高率であるが,70歳以上の高齢者を対象にするとあまり変わらない。 |
ポドサイトとボウマン囊上皮(壁側上皮)に関する次の記述のうち誤りはどれか。2つ選べ。
| a | ボウマン囊上皮はポドサイトに分化しうる。 |
| b | ポドサイトは病的状態でボウマン囊上皮になりうる。 |
| c | ポドサイトとボウマン囊上皮の細胞分裂能は同等である。 |
| d | ボウマン囊上皮は病的状態でポドサイト特異的マーカーを発現しうる。 |
| e | ポドサイトの特徴は,細胞間接着装置の位置に細胞嵌合があることである。 |
問題2.
ヒトのネフロン数について正しいのはどれか?
| a | 母胎栄養に影響される。 |
| b | 出生時体重と関連する。 |
| c | 幼児期頃まで増加する。 |
| d | 成人以降は変わらない。 |
| e | 皮膜下近傍皮質のほうが皮髄境界近傍皮質よりも多い。 |
腎性貧血に関する次の記述のうち誤りはどれか。2つ選べ。
| a | 糖尿病では推算糸球体ろ過量が正常であっても腎性貧血を来すことがある。 |
| b | 鉄欠乏性貧血でエリスロポエチン(EPO)抵抗性となるのは,赤血球前駆細胞のEPO受容体発現低下による。 |
| c | 線維芽細胞増殖因子23(FGF23)が腎性貧血増悪の原因の一つであるという説がある。 |
| d | 透析患者において,TSATが20%程度で赤血球造血刺激因子製剤(ESA)の効果が一番強く出る。 |
| e | 血液透析患者における積極的な鉄投与は心不全を減らすが,心筋梗塞は減らさない。 |
問題2.
HIF-PH阻害薬に関して,誤っているのはどれか?1つ選べ。
| a | HIF-PH阻害薬は慢性炎症のある患者に対しても造血効果が期待できる。 |
| b | HIF-PH阻害薬は鉄利用効率が高く,鉄剤の補充は不要である。 |
| c | HIF-PH阻害薬投与時に注意すべき患者背景として,悪性腫瘍が挙げられる。 |
| d | HIF-PH阻害薬投与によって血清フェリチン値および血清ヘプシジン値は低下する。 |
| e | HIF-PH阻害薬は保存期,透析期いずれのCKD患者にも使用できる。 |
SARS-CoV2に対するmRNAワクチン接種後に生じる腎炎として現在までに報告が多い腎疾患を2つ選べ。
| a | IgA 腎症 |
| b | 膜性腎症 |
| c | 微小変化型ネフローゼ症候群 |
| d | 急性腎障害 |
| e | ANCA関連腎炎 |
問題2.
アルポート症候群に関して誤りはどれか。2つ選べ。
| a | X染色体連鎖型の遺伝形式をとる患者は約半数である。 |
| b | ナンセンス変異を有する男性患者とミスセンス変異を有する男性患者では,前者の方が末期腎不全に進行する年齢が若い。 |
| c | RAS阻害薬は腎障害の進行防止に有用である。 |
| d | 診断のための遺伝子検査は保険承認されている。 |
| e | 女性患者が末期腎不全に進行することは稀である。 |
問題3.
SGLT2阻害薬について正しいものを2つ選べ。
| a | 1型糖尿病患者にも安全に使用できる。 |
| b | 投与後にeGFRが上昇する。 |
| c | 血圧を上げる。 |
| d | ヘモグロビンが上昇する。 |
| e | 尿酸が低下する。 |
問題4.
急性腎障害(AKI)に関する記述のうち誤っているものはどれか。
| a | AKIは,血清クレアチニンの上昇や尿量の減少によって臨床的に定義される症候群である。 |
| b | 動物モデルでは病態の再現に限界がある。 |
| c | DNA損傷応答機構はAKI治療標的となる可能性がある。 |
| d | HIF-PH阻害薬はAKI治療薬として投与可能である。 |
| e | 老化細胞除去も将来的な治療法として期待される。 |
問題5.
FGF23に関する次の記述のうち誤りはどれか。2つ選べ。
| a | FGF23は骨から分泌され,腎臓を主な標的臓器とするホルモンである。 |
| b | FGF23はFGF受容体に高い親和性で結合する。 |
| c | FGF23はリン利尿作用と活性型ビタミンDの合成促進作用がある。 |
| d | 慢性腎臓病の進行過程で,FGF23は血清リンよりも早期に上昇し始める。 |
| e | FGF23が上昇すると尿細管障害が発生する。 |
高血圧の腎性機序において,尿細管でのナトリウム再吸収を決定するのに重要な部位はどこか。2つ選べ。
| a | 近位尿細管 |
| b | Henle係蹄太い上行脚 |
| c | 遠位尿細管 |
| d | 皮質集合管 |
| e | 髄質集合管 |
問題2.
次の記述のうち正しいものはどれか。2つ選べ。
| a | カリウム摂取量は血圧値と正の相関関係がある。 |
| b | カリウム摂取は遠位尿細管の食塩再吸収を抑制する。 |
| c | FGF23は近位尿細管でのリン酸塩の再吸収を促進する。 |
| d | SGLT2阻害薬の腎保護効果は複数の臨床研究で示されている。 |
| e | SGTL2阻害薬の血糖降下作用はインスリンの分泌促進に由来する。 |
問題3.
体内におけるナトリウムの調節に関して次の記述のうち正しいものはどれか。2つ選べ。
| a | 長期的に食塩の摂取量が増加すると経時的に飲水量は増加する。 |
| b | 食塩の摂取量が増加すると蛋白合成が亢進し,体内は同化にかたむく。 |
| c | 腎不全においては尿の濃縮を促進するため尿素をはじめとする浸透圧物質の産生が亢進している。 |
| d | 血液中のナトリウムと組織におけるナトリウムは常に平衡状態にある。 |
| e | 皮膚におけるナトリウム制御には免疫細胞が関与している。 |
問題4.
MR拮抗薬の投与を積極的に検討するべき病態として,不適切なものはどれか。1つ選べ。
| a | 原発性アルドステロン症 |
| b | 偽アルドステロン症 |
| c | 治療抵抗性高血圧 |
| d | 妊娠高血圧症候群 |
| e | 糖尿病性腎症 |
問題5.
ナトリウム利尿ペプチド,ARNIについて次のうちから正しいものを1つ選べ。
| a | ナトリウム利尿ペプチドの作用はサイクリックAMPによって伝えられる。 |
| b | ネプリライシンはナトリウム利尿ペプチドのみを分解する。 |
| c | 心不全患者においてARNIは降圧効果のほか,NT-proBNP改善効果を持つ。 |
| d | ナトリウム利尿ペプチドは輸入細動脈を収縮させる。 |
| e | ANPの受容体グアニリルシクラーゼAは腎では集合管のみに発現している。 |
問題6.
腎デナベーションに関する次の記述のうち誤りはどれか。2つ選べ。
| a | 高血圧患者に対する腎デナベーションは経カテーテル的に施行される。 |
| b | 透析施行中の難治性高血圧に対して腎デナベーションが推奨されている。 |
| c | 腎デナベーションの降圧効果は高血圧の成因によって異なることが想定される。 |
| d | 腎デナベーションの降圧効果と安全性は最大3 年間持続することが報告されている。 |
| e | 腎デナベーションは高血圧患者の脳心血管イベントを抑制することが複数の無作為化比較試験から明らかにされている。 |
免疫チェックポイント阻害薬投与中の患者に生じる腎障害に関して,正しいのはどれか。1つ選べ。
| a | T細胞に発現するPD-1が腫瘍細胞に発現しているPD-L1と結合すると,T細胞の細胞傷害活性が亢進する。 |
| b | 免疫関連有害事象としての腎障害で,もっとも障害されることの多い部位は糸球体である。 |
| c | 免疫チェックポイント阻害薬に関連した急性腎障害(AKI)は,薬剤投与3日後までに発症することがほとんどである。 |
| d | 免疫チェックポイント阻害薬投与患者におけるAKI発症のリスク因子としてプロトンポンプ阻害薬が報告されている。 |
| e | AKIからの回復後,免疫チェックポイント阻害薬を再開した際のAKI再発率はおよそ80%である。 |
問題2.
幹細胞移植後の腎障害に関する次の記述のうち,正しいものはどれか。2つ選べ。
| a | 幹細胞移植後の膜性腎症は急性移植片対宿主病(GVHD)との関連が報告されている。 |
| b | 移植関連血栓性微小血管障害症(TA-TMA)ではADAMTS13活性が10%未満の症例が多い。 |
| c | 幹細胞移植後のAKIの重症度が進行するにつれて死亡率も上昇する。 |
| d | 幹細胞移植後のAKIは腎生検で診断に至ることが多い。 |
| e | 移植関連血栓性微小血管障害症(TA-TMA)の原因の一つにカルシニューリン阻害薬がある。 |
問題3.
腎臓移植待機患者あるいは腎移植後患者におけるがんスクリーニングおよび治療に関する次の記述のうち,誤りはどれか。1つ選べ。
| a | 治療中のがんを有する患者でも腎移植の適応となり得る。 |
| b | 腎移植後患者には少なくとも1年に1回の皮膚がんのスクリーニングを推奨する。 |
| c | 腎移植後患者の皮膚扁平上皮がんにおいては,免疫抑制剤としてmTOR阻害薬を使用することでがん再発のリスクを下げることができる。 |
| d | 腎移植後患者のがんに免疫チェックポイント阻害薬を使用する際には,急性拒絶反応のリスクが約40%あるので注意が必要である。 |
| e | 腎移植後患者の移植後リンパ増殖性疾患(PTLD)は,ドナーとレシピエントのEBウィルス罹患歴のミスマッチがリスク因子である。 |
問題4.
腎部分切除術について,正しいものを選べ。
| a | 直径4cm以上の腎腫瘍に対しては行われない。 |
| b | 温阻血時間は25分以内が腎機能温存のため推奨される。 |
| c | 直径2cmの腎盂限局の尿路上皮がんに対して行われる。 |
| d | 両腎が存在する場合,片側手術での術後腎機能は,術前の60~70%となる。 |
| e | ロボット支援手術は開腹手術に比較して術後腎機能が良好である。 |
問題5.
腎機能低下患者へのがん薬物療法に関する次の記述のうち,誤りはどれか。2つ選べ。
| a | 日本人の糸球体濾過速度推算式に基づいたeGFRの算出により,すべての抗がん薬の投与設計を実施することが適切である。 |
| b | 腎機能低下患者へのカルボプラチンの投与量は,Calvert式を用いて算出される。 |
| c | 透析患者では,適切な時間に透析を実施して,投与したシスプラチンを体内から除去することが推奨されている。 |
| d | 低アルブミン血症患者では,薬物の遊離型分率の上昇により副作用が増強される可能性がある。 |
| e | 透析患者では,肝代謝型薬物でも代謝物の排泄が遅延して副作用が発現する可能性がある。 |
問題6.
がん既往のある,あるいは担がんの慢性腎臓病(CKD)患者における貧血に関して以下のうち,誤っているものを2つ選べ。
| a | 血清フェリチン値が低いにもかかわらずトランスフェリン飽和度(TSAT)が高い時には,がんの存在を疑う。 |
| b | がんが癒えたがん既往のある患者において,赤血球造血刺激因子製剤(ESA)は安心して使ってよい。 |
| c | 担がん患者において,低酸素誘導因子プロリン水酸化酵素(HIF-PH)阻害薬を使う際には,注意を要する。 |
| d | 担がん患者では血栓症が起こりやすいので,鉄をESAやHIF-PH阻害薬よりも優先して使うべきである。 |
| e | CKDステージG3までは,がんを有する糖尿病患者においても,鉄が充足していればsodium-glucose cotransporter 2(SGLT2)阻害薬によって貧血は改善することが多い。 |
International Society of Nephrology / Renal Pathology Society(ISN/RPS)分類Ⅲ型,Ⅳ型のループス腎炎の寛解導入療法で,第一選択となる薬剤を2つ選べ。
| a | タクロリムス |
| b | リツキシマブ |
| c | アザチオプリン |
| d | シクロホスファミド |
| e | ミコフェノール酸モフェチル |
問題2.
急速進行性糸球体腎炎(RPGN)に関する次の記述のうち正しいものはどれか。2つ選べ。
| a | RPGNの原疾患としては抗糸球体基底膜(GBM)抗体型腎炎が最多である。 |
| b | 抗好中球細胞質抗体(ANCA)関連血管炎の病態形成に好中球細胞外トラップが関与する。 |
| c | ANCA関連血管炎に対するリツキシマブの治療効果はメトトレキサートに非劣性であることが大規模臨床試験で示された。 |
| d | 新型コロナウイルスワクチン接種後の抗体獲得能はリツキシマブ投与患者で低下する。 |
| e | 組織学的にPauci-immune型のRPGNに対しC5a受容体阻害薬は無効である。 |
問題3.
わが国のネフローゼ症候群患者に関する次の記述のうち正しいものはどれか。2つ選べ。
| a | 微小変化型ネフローゼ症候群(MCNS)患者の寛解率は高いが,半数が再発する。 |
| b | 発症時のアルブミン濃度が高いほど,早期に寛解しやすい。 |
| c | ネフローゼ症候群患者は高血圧を伴わなくても,アンジオテンシンⅡ受容体拮抗薬(ARB)/ アンジオテンシン変換酵素阻害薬(ACEi)が処方されていることが多い。 |
| d | 巣状分節性糸球体硬化症(FSGS)患者のうち,tip variantの患者の予後は比較的良好である。 |
| e | 新型コロナウイルスワクチン接種後のネフローゼ症候群再発リスクは極めて低い。 |
問題4.
小児特発性ネフローゼ症候群に関する次の記述のうち正しいものはどれか。2つ選べ。
| a | 発症率は欧州人と比較してアジア人で高い。 |
| b | ステロイド感受性ネフローゼ症候群は基本的に単一遺伝子疾患である。 |
| c | 初発時ステロイド感受性でその後の再発で抵抗性化した症例に関しては,遺伝子検査を行うことは推奨されない。 |
| d | リツキシマブの使用により,ネフローゼ症候群の治癒が期待できる。 |
| e | 遺伝子異常を伴うFSGSは腎移植後再発のハイリスクである。 |
問題5.
膜性腎症に関する次の記述のうち誤りはどれか。2つ選べ。
| a | 腎生検を行わなくても血中PLA2R IgGが陽性であれば,一次性膜性腎症と診断して治療を開始してもよい。 |
| b | 一次性膜性腎症に占めるPLA2R関連膜性腎症の割合には国や地域による差がある。 |
| c | 一次性膜性腎症では糸球体に沈着するIgGのサブクラスはIgG4が主体である。 |
| d | PLA2R関連膜性腎症において血中PLA2R抗体濃度は疾患の免疫的病勢を反映している。 |
| e | 日本において成人発症の膜性腎症の初期治療薬としてリツキシマブは保険適用されている。 |
問題6.
C3腎症に関する次の記述のうち誤りはどれか。2つ選べ。
| a | 光学顕微鏡では膜性増殖性糸球体腎炎パターンを呈する。 |
| b | 蛍光抗体法では,免疫グロブリンの沈着と比し,C3の沈着が2段階以上の強い蛍光強度を示す。 |
| c | 主に補体古典経路が関与する。 |
| d | 遺伝子異常が同定される症例は,70%以上と高率である。 |
| e | C3 nephritic factor(C3Nef)はC3腎症の診断に有用である。 |
問題7.
IgA腎症の診療に関する次の記述のうち正しいのはどれか。2つ選べ。
| a | IgA 腎症の予後予測ツールとして開発されたInternational Risk Prediction toolはWebサイトかスマートフォン用のアプリケーションで使用可能である。 |
| b | 国際的にステロイド治療はIgA腎症治療の第一選択である。 |
| c | IgA腎症に対する扁桃摘出は世界的に受け入れられた治療である。 |
| d | Sodium-glucose cotransporter 2(SGLT2)阻害薬のDapagliflozinは糖尿病を有するIgA腎症に対してのみ使用可能である。 |
| e | 新型コロナウイルスワクチン接種後に肉眼的血尿を呈するIgA腎症の症例が存在する。 |
ミネラルコルチコイド受容体(MR)拮抗薬に関する次の記述のうち誤りはどれか。2つ選べ。
| a | エサキセレノン,フィネレノンでは性ホルモン関連副作用が稀である。 |
| b | フィネレノンは,ほかのMR 拮抗薬と比較して半減期が最も長く,降圧作用も強い。 |
| c | フィネレノンは,2型糖尿病合併慢性腎臓病(CKD)患者(レニン·アンジオテンシン系阻害薬投与下ACR ≧ 30,eGFR ≧ 25)の心血管系予後と腎予後を改善する。 |
| d | 治療抵抗性高血圧では,血漿アルドステロン濃度が低値~正常の症例ではMR 拮抗薬の降圧作用は弱く推奨されない。 |
| e | SGLT2阻害薬はMR拮抗薬による高カリウム血症のリスクを低減することが報告されている。 |
問題2.
CKD患者における鉄代謝について誤りはどれか。2つ選べ。
| a | Hepcidinは腎臓から排泄される。 |
| b | Hepcidinはエリスロフェロンにより誘導される。 |
| c | Hepcidinは消化管からの鉄吸収を阻害する。 |
| d | HIF-PH阻害薬はトランスフェリンを抑制する。 |
| e | HIF-PH阻害薬はHepcidinを抑制する。 |
問題3.
CKDのリスクとなるのはどれか。
1. 晩産
2. 母体糖尿病
3. 子宮内発育遅延
4. 新生児期の急性腎障害
5. 乳幼児期の体重増加不良
| a | (1,2,3) |
| b | (1,2,5) |
| c | (1,4,5) |
| d | (2,3,4) |
| e | (3,4,5) |
問題4.
泌尿器科疾患の2022年の進歩に関する次の記述のうち正しいものはどれか。2つ選べ。
| a | 1期(7cm以下)の淡明細胞癌に対してペンブロリズマブを用いた術後補助療法は無病生存期間の延長を期待できる。 |
| b | 局所進行性・転移性尿路上皮癌に対するエンホルツマブ・ベドチンは免疫チェックポイント阻害薬の治療歴がない患者が対象である。 |
| c | 周囲脂肪織へ浸潤する尿路上皮癌(T3)に対する確立した術後補助療法はない。 |
| d | 転移性前立腺癌が見つかった場合に最初からドセタキセル療法を行うのは過剰医療ではない。 |
| e | ロボット支援手術の対象に,副腎摘出術や根治的腎摘除術が含まれる。 |
ヒトの血液型で,腸細菌叢に影響を及ぼすと報告されたのはどれか。
| a | Rh血液型 |
| b | MNS血液型 |
| c | ABO血液型 |
| d | Duffy血液型 |
| e | P関連血液型 |
問題2.
食品由来のオリゴ糖・食物繊維などを摂取することで腸細菌叢を調整することを何と呼ぶか。
| a | ディスバイオーシス |
| b | プレバイオティクス |
| c | プロバイオティクス |
| d | シンバイオティクス |
| e | マイクロバイオータ |
問題3.
メタボリックシンドローム(MetS)とその腸内細菌に関する次の記述のうち正しいのはどれか。2つ選べ。
| a | 本邦のMetSの診断基準ではインスリン抵抗性を最上流においている。 |
| b | Bacteroidetes/Firmicutes比を高くすることが,正常の腸内細菌の分布に近い状態とされている。 |
| c | Lactobacillus casei Shirotaの投与がprediabeticかMetSの患者への有効性が認められている。 |
| d | シンバイオティクスのプレバイオティクスとして,ショ糖が用いられている。 |
| e | MetSにおいて腎障害を伴うオッズ比は約2倍である。 |
問題4.
急性腎障害(AKI)と腸管環境の関係のうち誤りはどれか。1つ選べ。
| a | AKIの発症は腸内細菌叢のディスバイオーシスを誘発する。 |
| b | AKIの発症は腸管上皮細胞の脆弱性を誘発する。 |
| c | 腸内細菌叢の変化はAKIの病態に関与する。 |
| d | AKIでは腸管脆弱性に伴い,腸内細菌関連分子が体内移入する。 |
| e | 腸内細菌由来短鎖脂肪酸は,尿毒症物質として臓器障害に働く。 |
問題5.
循環器疾患・腎臓病・腸内環境に関する次の記述のうち誤りはどれか。2つ選べ。
| a | 慢性腎不全での維持透析患者の死亡原因として,心血管疾患が約3分の1を占める。 |
| b | 腎臓病・循環器疾患の原因となる特定の腸内細菌が同定されており,バイオマーカーや治療標的として注目されている。 |
| c | 腸内細菌は,ある種の内服薬で菌叢が変化することが示されている。 |
| d | 腸内細菌は,主に代謝・免疫を介して宿主の生体機能に関与し,生体の恒常性の維持や疾患の発症や増悪にも影響している。 |
| e | 腸内細菌関連代謝物であるトリメチルアミンNオキシド(TMAO)は心血管イベントを増加させ,腸内細菌の除菌や産生酵素阻害によってイベント抑制効果が示されている。 |
正常妊娠前半期に認められる変化はどれか。2つ選べ。
| a | 尿蛋白の増加 |
| b | 血漿浸透圧の上昇 |
| c | 循環血漿量の増加 |
| d | 全身血管抵抗の上昇 |
| e | 血清クレアチニン値の上昇 |
問題2.
慢性腎臓病(CKD)患者の妊娠において誤りはどれか。1つ選べ。
| a | レニン-アンジオテンシン系(RAS)阻害薬の胎児毒性は明らかであり,妊娠判明後,ただちに中止する。 |
| b | 腎機能障害および蛋白尿が進行するほど妊娠合併症のリスクは高い。 |
| c | 妊娠中の腎生検は合併症の頻度が低い妊娠中期以降に行う。 |
| d | 透析患者の妊娠は,健康な妊婦と比較して生児を得る確率が低い。 |
| e | 妊娠高血圧症候群の既往は末期腎不全のリスクとなる。 |
問題3.
38歳の女性。これまで学校や職場検診で異常を指摘されたことはない。第一子妊娠26週ごろから高血圧(150/100mmHg)が出現したが腎機能や尿所見の異常なく,降圧薬で経過観察されていた。妊娠29週ごろから軽度の蛋白尿が出現,妊娠34週には蛋白尿4g/日に至り浮腫も増加した。妊娠36週で腎機能の急激な増悪(クレアチニン1.6mg/dL)と蛋白尿増加,血圧上昇(170/130mmHg)を認め緊急入院,帝王切開で出産した。経過中,尿潜血(±),尿糖(-)であった。出産後14日目に腎生検が施行された。代表的な糸球体の光学顕微鏡(PAM染色,図A)および電子顕微鏡所見(図B)を示す。IFは陰性である。この患者で正しいのはどれか。2つ選べ。
| a | 膜性増殖性糸球体腎炎が疑われる。 |
| b | この糸球体の病変の首座はフィブリンの析出を伴う係蹄壊死である。 |
| c | 本症例の糸球体でみられる内皮障害像は非可逆性である。 |
| d | 本疾患の病因に,螺旋動脈のリモデリング不全による胎盤虚血が考えられている。 |
| e | 本疾患の発症の予測因子として,血清中の可溶性fms様チロシンキナーゼ-1(sFlt-1)の胎盤増殖因子(PlGF)に対する比率(sFlt-1/PlGF比)の上昇が有効である。 |

問題4.
治療上の有益性が危険性を上回ると判断される場合,妊娠初期から投与が許容される薬剤は次のうちどれか。2つ選べ。
| a | アンジオテンシンⅡ受容体拮抗薬(ARB) |
| b | ニフェジピン |
| c | シクロスポリン |
| d | シクロホスファミド |
| e | ミコフェノール酸モフェチル(MMF) |
問題5.
腎移植後患者の妊娠・出産について正しい組み合せはどれか。
a. 移植を行うことにより透析よりも妊孕性は向上する。
b. 腎移植後妊娠では妊娠高血圧腎症(PE)の割合は低くなる。
c. 拒絶反応を惹起するため,移植時の妊娠準備として免疫抑制剤の変更は望ましくない。
d. 授乳は免疫抑制薬が移行するため禁忌である。
e. 生体腎移植ドナーの腎提供後の妊娠には一定のリスクがある。
| 1 | (a,b) |
| 2 | (a,e) |
| 3 | (b,c) |
| 4 | (c,d) |
| 5 | (d,e) |
問題6.
慢性腎臓病(CKD)のリスクとして誤りはどれか。2つ選べ。
| a | 早産 |
| b | 低出生体重 |
| c | SGA |
| d | 晩産 |
| e | 高身長 |
問題7.
妊娠高血圧症候群に関する次の記述のうち,誤りはどれか。2つ選べ。
| a | 妊娠前に高血圧を認めない女性が妊娠した。妊娠20週以降に高血圧と胎児発育不全を認めた。尿蛋白は認めなかった。本疾患の診断は妊娠高血圧腎症(PE)である。 |
| b | PEは,正常妊娠女性と比較して将来の高血圧症の発症リスクが高い。 |
| c | 産後授乳中の女性に高血圧を認め,降圧加療を開始することとなった。妊娠中の使用が禁忌であるアンジオテンシン変換酵素(ACE)阻害薬は授乳中も使用禁忌である。 |
| d | PEを認めた女性に,産後尿蛋白が遷延しているが,慢性腎炎の鑑別は必要ない。 |
| e | 妊娠高血圧症候群を経験した女性は,正常妊娠女性と比較して次回妊娠時に妊娠高血圧症候群再発のリスクが高い。 |
アンジオテンシン受容体ネプリライシン阻害薬(ARNI,サクビトリル・バルサルタン)の心腎連関における効果に関する記述のうち,誤りはどれか。2つ選べ。
| a | PARADIGM-HF試験においてARNIは左室駆出率の低下した心不全患者の心血管死亡をアンジオテンシン変換酵素(ACE)阻害薬よりも有意に低下させた。 |
| b | PARAGON-HF試験においてARNIは左室駆出率の保持された心不全患者の心血管死亡をアンジオテンシンⅡ受容体拮抗薬(ARB)よりも有意に低下させた。 |
| c | PARADIGM-HFおよびPARAGON-HF試験共にARNIはACE阻害薬またはARBと比較して血中クレアチニン値上昇や血中カリウム値上昇の有害事象が少なかった。 |
| d | PARADIGM-HF試験においてARNIはACE阻害薬と比較して左室駆出率の低下した心不全患者の尿中アルブミン/クレアチニン比を低下させたが,推算糸球体濾過量(eGFR)低下の傾きは悪化させた。 |
| e | PARADIGM-HFおよびPARAGON-HF試験の統合解析においてARNIはACE阻害薬またはARBと比較し心不全患者の複合腎イベントの有意な抑制効果を示した。 |
問題2.
次のうち正しいのはどれか。1つ選べ。
| a | 線維芽細胞増殖因子(FGF)23は遠位尿細管での2a型ナトリウム-リン共輸送体(NPT2a)の発現を低下させる。 |
| b | FGF23はFGF20サブファミリーに属する。 |
| c | FGF23はレニン-アンジオテンシン-アルドステロン系と関連している。 |
| d | FGF23の受容体の中で重要なものはFGF受容体3である。 |
| e | eGFR>60mL/分/1.73m2では血中FGF23濃度の上昇は心血管疾患と関係しない。 |
問題3.
糖尿病性腎臓病と心不全の両方に対する予後改善効果が大規模臨床試験で確認されていない薬剤はどれか。
1. SGLT2阻害薬
2. HIF-PH阻害薬
3. エリスロポエチン製剤
4. ミネラルコルチコイド受容体拮抗薬(MRA)
5. ARB
| a | (1,2) |
| b | (1,5) |
| c | (2,3) |
| d | (3,4) |
| e | (4,5) |
問題4.
MR拮抗薬に関する記述のうち,誤りはどれか。2つ選べ。
| a | エサキセレノンはMR選択性が高い。 |
| b | フィネレノンの臓器保護効果には降圧の影響が大きい。 |
| c | エプレレノンは蛋白尿を有する糖尿病患者に適応がある。 |
| d | フィネレノンは糖尿病性腎症に対する心・腎保護効果が示された。 |
| e | スピロノラクトンは左室収縮能が低下した心不全(HFrEF)に有用である。 |
問題5.
腎静脈圧の上昇に伴う腎機能障害(腎うっ血)に関する記述のうち,誤りはどれか。2つ選べ。
| a | 腎うっ血には体液量の過剰が主たる病態となるため尿中ナトリウム排泄は亢進している。 |
| b | 腎うっ血の病態の悪化に伴い,超音波による腎静脈圧波形は連続性となる。 |
| c | 腎うっ血の存在は,心不全患者における生命予後不良因子である。 |
| d | 腎うっ血時には腎間質圧の上昇により血流不全が生じる。 |
| e | 心不全患者における入院中に発生する腎機能障害には,心拍出量の低下よりも中心静脈圧の上昇のほうが強く相関する。 |
わが国の保存的腎臓療法(conservative kidney management:CKM)について正しいものはどれか。1つ選べ。
| a | 法的免責が得られている。 |
| b | 維持透析終了後の患者生命予後は,およそ1か月である。 |
| c | 80歳以上では透析見合わせ(非開始)が,透析終了よりも多い。 |
| d | 透析見合わせ(非開始)後の患者生命予後は,およそ2週間以内である。 |
| e | 腎代替療法選択時には,透析・移植と同時・並列にCKMの説明を要する。 |
問題2.
医療の選択プロセスにおける基本的な考え方について,正しいものはどれか。2つ選べ。
| a | インフォームド・コンセント(IC)の主体は医師であり患者の位置付けは従たるものである。 |
| b | 日本の医療過誤紛争において,IC不備が直接不法行為を構成するわけではない。 |
| c | 医師の説明義務は努力義務であって,その不備に対する法的責任を問われることはない。 |
| d | 共同意思決定(SDM)は,今後の医療での意思決定において標準的な手続きと考えられる。 |
| e | ACP(advanced care planning)の開始時期は,患者の不安を避けるためにも腎代替療法の必要性が高まる慢性腎臓病(CKD)ステージG5とすべきである。 |
問題3.
腎代替療法の介入・開始のプロセスについて正しいものはどれか。
| a | 透析導入は早期開始群〔糸球体濾過量(GFR)10mL/分/1.73m2以上〕の予後が良いとされている。 |
| b | 腎代替療法指導管理料はeGFR30mL/分/1.73m2未満のCKD患者において算定される。 |
| c | 事前指示書は,患者が腎代替療法を必要とした時にCKMを選択する旨を記した書面である。 |
| d | 意思確認ができない状態の患者でのCKMの決定は親族でなければならない。 |
| e | ACPは腎代替療法が必要になった時点で,以降の方向性を決める会議である。 |
問題4.
以下の説明因子のなかで,血液透析導入後の短期生命予後との関連性がもっとも弱いものはどれか。
| a | 年齢 |
| b | バスキュラーアクセス(動静脈吻合)準備 |
| c | 血清アルブミン値 |
| d | 血清クレアチニン値 |
| e | C反応性蛋白(CRP) |
問題5.
腎機能が著明に低下し入院してきたCKMの患者が呼吸困難を訴えるようになった場合,正しいものはどれか。1つ選べ。
| a | フェンタニル貼付薬は有用性が高い。 |
| b | オキシコドン注射薬は保険適用がない。 |
| c | モルヒネ注射薬は安全なオピオイドである。 |
| d | 患者・家族を説き伏せて血液透析を開始する。 |
| e | 緩和ケアチームに相談すると緩和ケア診療加算が算定できる。 |
問題6.
患者がCKMを希望されてきた際に,留意が必要なものとして,誤りはどれか。1つ選べ。
| a | 精神疾患(特にうつ病)の有無 |
| b | 認知機能の評価 |
| c | 医療機関の意向 |
| d | 意思決定能力の評価 |
| e | アドバンス・ケア・プランニング実施の有無 |
問題7.
医療倫理と臨床倫理に関する次の記述のうち,正しいものはどれか。1つ選べ。
| a | 違法でなければ倫理的にも問題ない。 |
| b | 「医は仁術」は日本独自の医療倫理である。 |
| c | 臨床倫理では症例ごとに一人ひとりの患者を中心に考える。 |
| d | 患者が認知症を有している場合は患者の家族に意思決定を依頼する。 |
| e | 医師は患者と家族に対して適切にICをしなければならない。 |
ネフリン(Nephrin)に関する次の記述のうち誤りはどれか。2つ選べ。
| a | ネフリンをコードする遺伝子はNPHS2である。 |
| b | ネフリンはスリット膜を構成する主要蛋白である。 |
| c | ネフリン遺伝子の変異は先天性ネフローゼ症候群の病因のひとつである。 |
| d | ネフリン遺伝子は小児ステロイド感受性ネフローゼ症候群の疾患感受性遺伝子と考えられている。 |
| e | 抗ネフリン抗体は膜性腎症の病態に関与すると考えられている。 |
問題2.
移植用臓器として近年,異種動物の臓器を利用した研究が進められている。移植用臓器として実際に脳死患者への移植が試みられた異種動物種は以下のどれか。
| a | ラット |
| b | カニクイザル |
| c | ブタ |
| d | ヒツジ |
| e | ヒヒ |
問題3.
IgA腎症に関する次の記述のうち,正しいのはどれか。
1. IgA腎症の予後分類を行ううえで,組織学的重症度分類と臨床的重症度分類が必要である。組織学的重症度分類において,急性病変と慢性病変を評価する必要があるが,メサンギウム細胞増殖は急性病変として評価しない。
2. 新型コロナワクチン接種後の肉眼的血尿が報告されているが,RNAワクチン接種後に多くみられ,女性に多くみられる。
3. 本症の予後を悪化させる因子として可能性が高いものは,蛋白尿,高血圧,肥満,喫煙,中等度の運動負荷である。
4. 本邦では口蓋扁桃摘出術(扁摘)およびステロイドパルス療法が多くの施設で広く施行され,一定の効果がみられている。国外からの報告では扁摘治療の有効性は示されておらず,日本と欧州のガイドラインでのみ推奨されている。
5. IgA腎症診療ガイドライン2020では,成人IgA腎症の治療アルゴリズムとして,推算糸球体濾過量(eGFR)30mL/分/1.73m2以上かつ尿蛋白量0.5g/日未満の場合は,薬物療法なしでの経過観察を基本としている。
| a | (1,2,3) |
| b | (1,2,5) |
| c | (1,4,5) |
| d | (2,3,4) |
| e | (3,4,5) |
高齢者の腎に関する次の記述のうち,誤りはどれか。1つ選べ。
| a | 腎血流量が低下する。 |
| b | 経年的に糸球体濾過量が低下する。 |
| c | 腎囊胞が増加する。 |
| d | 尿細管濃縮力が増大する。 |
| e | 腎サイズが縮小する。 |
問題2.
透析患者に関する次の記述のうち,誤りはどれか。2つ選べ。
| a | 2022年末において75歳以上の患者が過半数を占めている。 |
| b | 腹膜透析患者は血液透析患者より平均年齢が低い。 |
| c | 腹膜透析患者は在宅血液透析患者より平均年齢が低い。 |
| d | 2022年末において60歳以上の患者が約80%を占めている。 |
| e | 2022年度の導入患者において60歳以上の患者が約80%を占めている。 |
Dent病に関する次の記述のうち,正しいのはどれか。
1. 病理組織所見は全節性硬化,巣状分節性糸球体硬化,間質の線維化,尿細管の萎縮など,非特異的である。
2. 常染色体顕性の疾患で,原因遺伝子としてCLCN5とOCRLが知られている。
3. 末期腎不全に至ることは稀である。
4. 本邦では3歳児検尿や学校検尿で発見されることが多い。
5. 腎の石灰化を認めることがある。
| a | (1,2,3) |
| b | (1,2,5) |
| c | (1,4,5) |
| d | (2,3,4) |
| e | (3,4,5) |
問題2.
Alport症候群に関する次の記述のうち,誤りはどれか。2つ選べ。
| a | Ⅳ型コラーゲンα鎖遺伝子の病的バリアントに起因する。 |
| b | X連鎖型の女性は保因者であるため,症状は軽症であり腎不全にはならない。 |
| c | 糸球体のⅣ型コラーゲン染色で,α5鎖はX連鎖型の男性では染色されず,女性では一部が染色されるが,全く正常の場合でもAlport症候群は否定できない。 |
| d | 治療は,レニン-アンジオテンシン系阻害薬およびシクロスポリンが推奨されている。 |
| e | 家族性血尿があり,腎不全の家族歴があれば,腎生検に先行して遺伝子検査を行う。 |
問題3.
20歳女性。13歳時の学校検尿で尿蛋白を指摘され,経過観察をされていた。最近,尿蛋白が増えてきたため腎臓内科を受診。腎生検を施行され,巣状分節性糸球体硬化症と診断された。
家族歴:父と父の姉が30代で末期腎不全。父方祖母も末期腎不全に至っている。
現 症:身長160cm 体重48kg
尿所見:蛋白(2+),糖(-),潜血(-)。尿蛋白2.6g/gCr
血液生化学所見:BUN 7.2mg/dL,Cr 0.54mg/dL,Alb 4.0g/dL
この患者の今後の治療方針について,最も当てはまるのはどれか。2つ選べ。
| a | 発症年齢が高いため遺伝性疾患は考えない。 |
| b | 本人や父の腎外症状(神経学的所見を含む)にも注意する必要がある。 |
| c | 家族歴より常染色体潜性遺伝形式を考える。 |
| d | 患者に説明なく,まずはアンジオテンシン変換酵素阻害薬を投与する。 |
| e | 濃厚な家族歴から遺伝性疾患も考慮する。 |
問題4.
Coenzyme Q10(CoQ10)腎症の特徴に関する次の記述のうち,誤りはどれか。2つ選べ。
| a | 成人には発症しない |
| b | CoQ10補充に反応しない |
| c | 常染色体潜性遺伝形式である |
| d | 腎病理組織学的にFSGS が特徴的である |
| e | COQ6遺伝子によるCoQ10腎症ではSRNSと難聴の合併が特徴である |
問題5.
巣状分節性糸球体硬化症(FSGS)を原疾患とした腎移植レシピエントに関する次の記述のうち,誤りはどれか。2つ選べ。
| a | 2009年の腎移植後ケアに関する国際的腎臓病ガイドライン機構(KDIGO)ガイドラインでは,FSGSを原発性腎疾患として有するレシピエントに対して,1週目まで1日1回の蛋白尿をスクリーニングすることを推奨している。 |
| b | 腎移植後FSGS再発の液性因子として,抗nephrin抗体が関与する可能性が報告された。 |
| c | 腎移植後FSGS再発の病態には補体が関与している。 |
| d | 腎移植後FSGS再発の治療として,保険適用の範囲で行える血漿交換は4回までである。 |
| e | FSGSは,小児末期腎不全の原因の第2位である。 |
PAS染色の写真を示す。次の記述のうち,正しいのはどれか。2つ選べ。
| a | Ⅳ型コラーゲンα鎖遺伝子の病的バリアントに起因する。 |
| b | 糸球体は3個観察され,細胞性半月体を1個認める。 |
| c | 糸球体にはメサンギウム基質の拡大を認める。 |
| d | メサンギウム融解を認める。 |
| e | 血管極には変化を認めない。 |
| f | 尿細管は高度に萎縮し間質の線維化を伴う。 |
問題2.
次の組み合わせのうち,誤りはどれか。2つ選べ。
| a | granular swollen epithelial cells(GSECs)─ミトコンドリア病 |
| b | 軽鎖円柱─PAS染色陽性 |
| c | 間質縞状線維化─カルシニューリン阻害薬(CNI) |
| d | 傍尿細管滲み込み病変─集合管 |
| e | 内膜弾性線維症─動脈硬化 |
問題3.
腎生検の免疫蛍光染色(IF)に関する次の記述のうち,誤りはどれか。2つ選べ。
| a | IF標本では,糸球体,尿細管,血管,間質において染色態度を観察し,糸球体以外の陽性像も必要に応じて記録する。 |
| b | 膜性腎症では基底膜に顆粒状の陽性像をIgG染色で認め,PLA2R染色やNELL1染色などの既知の標的抗原に対する追加染色をすることで病態の理解に役立つ。 |
| c | 抗GBM病ではIgG染色で糸球体基底膜に線状の陽性所見を認め,電子顕微鏡像の高電子密度沈着物に相当する所見である。 |
| d | アミロイドーシスの軽鎖染色では,一般的には凍結標本よりもホルマリン固定標本を用いた染色が感度よく,判定に適している。 |
| e | ホルマリン固定では蛋白が架橋されて抗原性の障害となるため,ホルマリン固定パラフィン包埋(FFPE)標本におけるIFでは蛋白溶解酵素や熱処理などを加えてから1次抗体で染色する。 |
問題4.
72歳の女性。これまで検診で異常を指摘されたことはない。2年前にCr 1.2mg/dL と軽度の腎機能低下が指摘されたが,尿所見に異常なし。1年前から高血圧(159/90mmHg)が出現し,降圧薬で経過観察されている。その後次第に腎機能が悪化したため,当院紹介受診(Cr 4.8mg/dL,UA 7.2mg/dL)。1か月後にCr 8.4mg/dL とさらに悪化したため,緊急入院した。腹部単純CTで両腎腫大を認めたが,明らかな囊胞形成は見られなかった。尿蛋白(+),尿潜血(+),尿中β2mg 872ng/mL,NAG 10.4U/Lだった。MPO-ANCA,PR3-ANCAは共に陰性であった。第7病日に行った腎生検を示す(Masson染色)。糸球体に半月体や増殖性変化を認めず,血管炎の所見も認めなかった。間質に線維化があるが炎症細胞浸潤は目立たなかった。IFは陰性である。この患者で正しいのはどれか。2つ選べ。
| a | 常染色体顕性(優性)遺伝である。 |
| b | 線毛病の一つである。 |
| c | Ⅳ型コラーゲンの免疫染色が有用である。 |
| d | Uromodulinの異常蓄積が疑われる。 |
| e | Mucin-1の遺伝子異常が疑われる。 |
慢性腎臓病(CKD)患者における運動療法について正しいのはどれか。2つ選べ。
| a | CKD患者には安静や運動制限が推奨されている。 |
| b | レジスタンス運動は最大筋力(1RM)の60~75%強度で実施する。 |
| c | 有酸素運動は自覚的運動強度(Borg指数)の15~17の強さで行う。 |
| d | 腎機能が低下すると筋力やバランス機能などの身体機能が低下しやすい。 |
| e | 有酸素運動は効果的であるが,レジスタンス運動は禁忌である。 |
問題2.
透析患者の運動療法に関する次の記述のうち,正しいのはどれか。1つ選べ。
| a | 透析中の運動療法は透析後半2時間で行う。 |
| b | 運動処方のFITTの原則とは,運動頻度,インターバル,強度および時間から構成される。 |
| c | 透析中に有酸素運動を行うことは困難である。 |
| d | 透析中の運動のほうが,非透析日の運動に比べて治療効果が高い。 |
| e | 透析患者において運動療法は運動耐容能,身体機能,標準化透析量(Kt/V)を改善する。 |
問題3.
CKD患者(保存期)における食事療法に関する次の記述のうち,誤りはどれか。2つ選べ。
| a | サルコペニアを合併したCKDステージG4の場合,たんぱく質制限を緩和する場合には1.3g/kgBW/日を目安にする。 |
| b | CKD患者の血清カリウム値を3.5mEq/L以上,5.0mEq/L未満に管理することが推奨されている。 |
| c | CKDのステージ進行および腎代替療法への導入を抑制する可能性があるため,管理栄養士が介入することが推奨されている。 |
| d | アルカリ性食品(野菜や果物など)の摂取は内因性酸産生量(NEAP)を抑制する。 |
| e | 食塩摂取制限とレニン・アンジオテンシン系阻害薬などの降圧薬は,降圧,尿蛋白減少に対して相乗的に働くことが示唆されている。 |
問題4.
慢性維持透析患者の食事と栄養について正しいのはどれか。3つ選べ。
| a | 平均たんぱく質摂取量は推奨値0.9~1.2g/kg/日に達していない。 |
| b | BMIと死亡リスクの間には逆J型の関係が見られる。 |
| c | 食塩摂取量は透析間の体重増加に関係する。 |
| d | 低栄養は血管石灰化に関係する。 |
| e | 肥満は心不全のリスクである。 |
透析患者が急激な低カルシウム血症を呈した際の対応として誤りはどれか。1つ選べ。
| a | 心電図検査を行う。 |
| b | 他院から骨粗鬆症治療薬が処方されていないか確認する。 |
| c | PTH値を測定する。 |
| d | カルシミメティクスを開始・増量する。 |
| e | 活性型ビタミンD製剤を開始・増量する。 |
問題2.
30歳の女性。10年ぶりに受けた健康診断で,血清クレアチニン1.3mg/dLの腎機能障害を指摘された。問診の結果,母親,母方叔父,母方祖母が末期腎不全と診断され血液透析を受けていたという情報が明らかになった。遺伝性腎疾患を疑う場合,最も可能性の低いものを1つ選べ。
| a | アルポート症候群 |
| b | ミトコンドリア病(MELAS) |
| c | 常染色体顕性多発性囊胞腎(ADPKD) |
| d | 常染色体顕性尿細管間質性腎疾患(ADTKD) |
| e | 遺伝性ネフロン癆(NPHP1遺伝子変異によるもの) |
問題3.
薬剤性腎障害について正しいものはどれか。2つ選べ。
| a | プベルル酸はFanconi症候群の原因物質である。 |
| b | アリストロキア酸による腎障害ではネフローゼ症候群を呈しやすい。 |
| c | COX-2選択阻害薬はCOX-2非選択薬より急性腎障害の発症頻度は低い。 |
| d | 尿中好酸球は薬剤性腎障害の早期発見に有用な尿中バイオマーカーである。 |
| e | 被疑薬中止においても腎障害が遷延する際は,ステロイド療法を検討してもよい。 |
問題4.
糖尿病性腎症(糖尿病関連腎臓病)について誤りはどれか。1つ選べ。
| a | 糖尿病症例で腎機能が低下する場合には必ずアルブミン尿が先行する。 |
| b | 我が国の新規透析導入原疾患の第一位であるが,近年はその割合は減少傾向にある。 |
| c | 一部のSGLT2阻害薬には慢性腎臓病に対する保険適用がある。 |
| d | レニン・アンジオテンシン系阻害薬は主に輸出細動脈の拡張を介して糸球体内圧を低下させる。 |
| e | 一部のGLP-1受容体作動薬には糖代謝の改善とともにアルブミン尿の減少が期待できる。 |
問題5.
次の設問の中で正しいものはどれか。1つ選べ。
| a | C3腎症は全て膜性増殖性糸球体腎炎(MPGN)の中に含まれる。 |
| b | M蛋白血症の高齢者において,腎生検で新鮮凍結切片を用いた蛍光免疫染色法による観察により,免疫グロブリン陰性,かつC3強陽性である場合にはC3腎症とみなして良い。 |
| c | 抗補体薬を使用する際に,推奨されるワクチン接種の施行によって肺炎球菌性肺炎,髄膜炎菌性髄膜炎の重症化は完全に予防できる。 |
| d | 現在使用可能な抗補体薬は,薬剤によって補体活性系の異なるポイントを制御する。 |
| e | 非典型溶血性尿毒症症候群(aHUS),抗好中球細胞質抗体(ANCA)関連腎炎,およびC3腎症が抗補体薬の現在の適応疾患である。 |
MGRS(monoclonal gammopathy of renal significance)に関して次の記述のうち正しいものはどれか。2つ選べ。
| a | MGUSに合併する全ての腎障害は,MGRSの腎障害の範疇に入る。 |
| b | MGRS関連腎病変の病型の1つに軽鎖円柱腎症がある。 |
| c | 血清の遊離軽鎖のκ/λ比の測定は,骨髄腫の診断だけではなく,治療のマーカーとしても重要であり,腎不全の有無でその基準値が異なる。 |
| d | MGRSの診断には腎生検が必須であり,MGRSでは全例,軽鎖染色に偏りを認める。 |
| e | MGRSの治療の基本はその背景にある血液増殖性疾患に対するclone-directed therapyである。 |
問題2.
M蛋白関連腎臓病のうち正しいのはどれか。2つ選べ。
| a | 骨髄生検でMGUSの診断であるが,腎生検で円柱腎症の診断になった場合は,血液学的疾患は多発性骨髄腫となる。 |
| b | ALアミロイドーシスの原因の軽鎖は,lambdaよりkappaが多い。 |
| c | MGRSの背景疾患は,形質細胞腫のみである。 |
| d | Crystal light chain proximal tubulopathyの原因の軽鎖は,lambdaよりkappaが多い。 |
| e | M蛋白関連腎臓病の腎生検の蛍光抗体法による軽鎖の検出は,プロナーゼ処理のパラフィン切片より凍結切片の方が感度がよい。 |
問題3.
血液疾患関連腎障害に関する次の記述のうち,誤りはどれか。2つ選べ。
| a | Lysozyme関連腎症は,慢性骨髄単球性白血病患者における腎障害の原因にはならない。 |
| b | Lysozyme関連腎症は,Lysozymeが近位尿細管で多量に再吸収され,尿細管上皮細胞内のリソソームに過剰に蓄積することで発症する。 |
| c | Lysozyme関連腎症では,Congo red染色で近位尿細管にサーモンピンクの染色性を認める。 |
| d | Crystalglobulin-induced nephropathyではネフローゼ症候群と皮膚症状を呈することが多い。 |
| e | Crystalglobulin-induced nephropathyでは小葉間動脈にフィブリノイド壊死を伴う血管炎病変を呈することがある。 |
問題4.
血液疾患関連腎障害の病理所見に関する次の記述のうち,誤りはどれか。2つ選べ。
| a | Fibrillary glomerulonephritisの診断には,DnaJ Heat Shock Protein Family(Hsp40)Member B9(DNAJB9)の免疫染色が有用である。 |
| b | Monoclonal immunoglobulin deposition diseaseが光学顕微鏡所見においてMPGN様に見られることは稀である。 |
| c | Monoclonal immunoglobulin deposition diseaseは糖尿病性腎症と類似した腎病理所見を呈する。 |
| d | Light chain proximal tubulopathyでは,近位尿細管上皮細胞に結晶性沈着物を認めないことがある。 |
| e | Proliferative glomerulonephritis with monoclonal immunoglobulin depositsは,腎病理所見において単クローン性免疫グロブリンの沈着が糸球体だけでなく,ボウマン囊や尿細管にも広範に認められる。 |
問題5.
血液悪性腫瘍の治療に伴う腎障害に関する次の記述のうち,正しいものはどれか。2つ選べ。
| a | 臍帯血移植は骨髄移植と比べGVHDが起こりやすく,移植関連血栓性微小血管症(TA-TMA)の頻度が高い。 |
| b | 造血幹細胞移植後の膜性腎症は,GVHDとしての免疫抑制療法で寛解が期待される。 |
| c | TA-TMAに対し,血漿交換療法の有効性が示されている。 |
| d | BCR-ABL阻害薬による腎障害は,腎臓でのBCR-ABL融合遺伝子発現を抑制するために起こる。 |
| e | マルチキナーゼ阻害薬による蛋白尿は可逆的であり,投与の中止によって軽快し得る。 |
問題6.
MGRS(monoclonal gammopathy of renal significance)に関する次の記述のうち,誤りはどれか。2つ選べ。
| a | ALアミロイドーシスが最多の病型である。 |
| b | 若年ALアミロイドーシスの標準治療は自家移植である。 |
| c | MGRSを示唆する所見として,尿蛋白,顕微鏡的血尿,遊離軽鎖異常がある。 |
| d | MGRSの治療は異常形質細胞に対する薬物療法と腎障害に対する支持療法に大別される。 |
| e | ALアミロイドーシスに対する薬物療法は,すでに沈着しているアミロイド蛋白を除去することが主目的である。 |
わが国におけるCKDの現状およびCKD対策に関する記載として,正しいのはどれか。2つ選べ。
| a | 2024年時点でのCKD患者数は約2,000万人,成人5人におよそ1人である。 |
| b | 新規透析導入患者数は増加が続いている。 |
| c | カルテの電子化が進んだ現代において,紙ベースのCKD連携紹介状様式は不要である。 |
| d | CKD対策における紹介基準は全国で統一を図るべきである。 |
| e | 特異的治療が可能な疾患の診断に繋げることを早期紹介の重要な目的として周知する必要がある。 |
問題2.
かかりつけ医における慢性腎臓病連携に関して次の記述のうち正しいものを1つ選べ。
| a | 「かかりつけ医から腎臓専門医・専門医療機関への紹介基準」では,CKD診断に必要な eGFR値および蛋白尿もしくはアルブミン尿の値により,紹介基準が決められている。 |
| b | 「かかりつけ医から腎臓専門医・専門医療機関への紹介基準」では,CKD重症度分類における最もハイリスクな赤のステージに該当する患者のみが,「原則紹介する」ことが推奨されている。 |
| c | 慢性腎臓病透析予防指導管理料の算定対象患者には糖尿病患者や現に透析療法を行っている患者は含まれない。 |
| d | 行政における慢性腎臓病重症化予防事業とは,市民を対象に,健康診断の結果を用いハイリスク患者の抽出を行い,保健指導を実施することであり,医師会との連携や受診勧奨はこの事業には含まれない。 |
| e | 令和5年3月厚生労働省から示された「電子版お薬手帳ガイドライン」において,eGFR値の記載は必須項目となっている。 |
問題3.
多職種連携による慢性腎臓病ケアに関する次の記述のうち誤りはどれか。2つ選べ。
| a | 薬剤師は腎臓病療養指導士取得の対象職種である。 |
| b | 慢性腎臓病透析予防指導管理料は月に2回まで算定可能である。 |
| c | 糖尿病透析予防指導管理料の算定の対象は糖尿病性腎症第1期の患者も含まれる。 |
| d | 慢性腎臓病透析予防指導管理料の算定のためには,看護師による介入は必須である。 |
| e | 成人の保存期CKDに対する多職種による教育的介入により,腎機能低下抑制効果が期待できる。 |
問題4.
腎移植後患者の妊娠・出産について正しい組み合せはどれか。
1.2018年「腎疾患対策検討会報告書」で示された年間新規透析導入患者数の成果目標は既に達成できた。
2.透析患者総数は増加の一途をたどっている。
3.慢性糸球体腎炎を原疾患とする透析導入患者では,生検等により確認された原疾患の割合が年々増加している。
4.透析導入患者では,男女とも肥満者(日本肥満学会の基準で定義されるbody mass index(BMI)が25 kg/m2以上)の割合が年々増加している。
5.透析導入患者の過半数は,透析導入された年のうちに死亡する。
| a | (1.2) |
| b | (1.5) |
| c | (2.3) |
| d | (3.4) |
| e | (4.5) |
ナトリウム・グルコース共輸送体-2(sodium glucose co-transporter2:SGLT2)阻害薬の慢性腎臓病(chronic kidney disease:CKD)・糖尿病関連腎臓病(diabetic kidney disease:DKD)に対する治療効果に関する記述のうち,正しい組合わせはどれか。1つ選べ。
1.CKD におけるSGLT2 阻害薬のchronic 推算糸球体濾過量(estimated glomerular filtration rate:eGFR)スロープ低下抑制効果は,尿アルブミンの程度によらず一貫して認められる。
2.SGLT2 阻害薬,グルカゴン様ペプチド-1(glucagon-like peptide-1:GLP-1)受容体作動薬,非ステロイド型ミネラルコルチコイド受容体(mineralocorticoid receptor:MR)拮抗薬の3剤併用療法によるCKD進行のリスク減少は約30%である。
3.『CKD診療ガイド2024』では,eGFR 15mL/分/1.73m2未満の患者でも SGLT2阻害薬の投与を新規に開始することが推奨されている。
4.SGLT2阻害薬は尿路感染症や性器真菌感染症のリスクを増加させるが,全感染症による入院のリスクも有意に増加させる。
5.SGLT2阻害薬は,赤血球造血を亢進させることが貧血改善の機序として知られている。
| a | (1.2) |
| b | (1.5) |
| c | (2.3) |
| d | (3.4) |
| e | (4.5) |
問題2.
非ステロイド型ミネラルコルチコイド受容体(mineralocorticoid receptor:MR)拮抗薬に関する次の記述のうち,誤りはどれか。2つ選べ。
| 1 | 非ステロイド型MR拮抗薬は,MRに対する選択性が高く,性ホルモン受容体への非特異的作用が少ない。 |
| 2 | フィネレノンは,MRに選択的に結合するだけでなく,転写補助因子の動員を阻害することで病的遺伝子発現を抑制する。 |
| 3 | エサキセレノンとフィネレノンは,いずれも高血圧症と2型糖尿病合併CKDに対して承認されている。 |
| 4 | 非ステロイド型MR拮抗薬は,ナトリウム再吸収を促進し,利尿作用を通じて心腎保護を発揮する。 |
| 5 | 非ステロイド型MR拮抗薬は,心臓と腎臓にほぼ均等に分布する一方,ステロイド型は腎臓に優位に分布する。このため,非ステロイド型は集合管MRへの作用が相対的に抑制されることで,高カリウム血症のリスクが低くなると報告されている。 |
問題3.
アンジオテンシン受容体ネプリライシン阻害薬(angiotensin receptor neprilysin inhibitor:ARNI)・GLP-1受容体作動薬に関する次の記述のうち,正しい組合わせはどれか。1つ選べ。
1.ネプリライシンはジペプチジルペプチダーゼ-4(dipeptidyl peptidase-4:DPP-4)を分解する。
2.ARNIはアンジオテンシン受容体拮抗薬(angiotensin receptor blocker:ARB)と比較して,強い降圧効果を示すことが報告されている。
3.ARNIは腎血流量を増加させることが報告されている。
4.ARNI投与により,投与当初は血中脳性ナトリウム利尿ペプチド(brain natriuretic peptide:BNP)濃度が低下する。
5.GLP-1受容体作動薬に関して,狭義の腎アウトカムであるeGFR50%の低下,末期腎不全,腎死,心血管死亡の複合エンドポイントを改善させた報告はない。
| a | (1.2) |
| b | (1.5) |
| c | (2.3) |
| d | (3.4) |
| e | (4.5) |
問題4.
腎とミトコンドリアの関連に関する次の記述のうち,誤りはどれか。2つ選べ。
| 1 | ミトコンドリアは,生体エネルギーであるアデノシン三リン酸(adenosine triphosphate:ATP)の産生を行うとともに,活性酸素種(reactive oxygen species:ROS)の制御,細胞死(アポトーシス,ネクローシス,フェロトーシス)の制御など,多岐にわたる役割を担っている。 |
| 2 | mitochondrial quality control(ミトコンドリア品質管理)は mitochondrial dynamics(ミトコンドリアの融合・分裂),mitophagy(マイトファジー),biogenesis(ミトコンドリア新生)といった一連の統合的な調節機構であり,腎疾患進行に関与する可能性がある。 |
| 3 | 遺伝性腎疾患であるミトコンドリア腎症は多様な臨床像を示し,巣状分節性糸球体硬化症から蛋白尿を呈する場合や,尿細管機能障害からBartter症候群やGitelman症候群を呈する場合もある。 |
| 4 | 遺伝性腎疾患であるミトコンドリア腎症は,ミトコンドリアDNAのみの病的バリアントによって発症する母系遺伝の疾患である。 |
| 5 | 腎臓のミトコンドリアは他臓器のミトコンドリアに比して,ATP産生の過程で産生される活性酸素種(ROS)が少ない。 |
問題5.
腎臓領域におけるエンドセリンに関する次の記述のうち,正しい組合わせはどれか。1つ選べ。
1.エンドセリンは2つの受容体が存在するが,利尿作用は主にA受容体が担っている。
2.SONAR試験でエンドセリン受容体拮抗薬の糖尿病関連腎臓病に対する腎保護効果が確認された。
3.PROTECT試験でエンドセリン受容体拮抗薬とレニン-アンジオテンシン-アルドステロン系(renin-angiotensin-aldosterone system:RAAS)阻害薬の合剤であるsparsentanのIgA腎症に対する腎保護効果が示された。
4.選択的エンドセリン受容体拮抗薬を使用すれば,腎疾患が存在しても浮腫は発症しづらい。
5.腎臓のエンドセリンA受容体は,集合管に多く分布する。
| a | (1.2) |
| b | (1.5) |
| c | (2.3) |
| d | (3.4) |
| e | (4.5) |
次のC3腎症に関する記述のうち,正しいのはどれか。正しいものを2つ選べ。
| a | Dense deposit disease(DDD)とC3腎症を診断するためには電子顕微鏡所見が必須である。 |
| b | C3腎症の光学顕微鏡における形態学的な病理所見は膜性増殖性糸球体腎炎(Membranoproliferative glomerulonephritis:MPGN)に限られる。 |
| c | C3腎症では,血中C3濃度が正常かつC4濃度が低下する場合が多い。 |
| d | 現在使用されている抗補体薬の標的分子は全て同じというわけではない。 |
| e | 全ての抗補体薬について,使用する際に髄膜炎菌ワクチン接種を必要とする。 |
問題2.
最新の抗補体療法に関する記述として,正しいものを1つ選べ。
| a | エクリズマブは,C5補体蛋白を標的とするモノクローナル抗体であり,3つの主要な補体経路の初期段階を直接的に阻害する。 |
| b | ラブリズマブの半減期がエクリズマブと比較して延長されているのは,分子の完全なヒト化とPEG化によるものである。 |
| c | イプタコパンは,補体因子B(FactorB)を阻害する小分子であり,代替経路のC3およびC5コンベルターゼの形成と下流代謝物の生成を阻害する。 |
| d | ペグセタコプランは,C3補体成分を標的とすることで,主に古典経路とレクチン経路の活性化を抑制する。 |
| e | アバコパンは,C5a受容体(C5aR)に選択的に結合することで,終末補体複合体(MAC)の形成を直接的に阻害する。 |
問題3.
IgA腎症と補体経路に関して正しいのはどれか。正しいものを2つ選べ。
| a | IgA腎症の腎組織ではC1q沈着が高頻度に認められる。 |
| b | 糸球体C4d沈着は腎予後不良と関連する。 |
| c | properdinは第二経路を抑制する補体因子である。 |
| d | 補体因子H関連タンパク質(FHR1/3)の遺伝的欠失はIgA腎症発症に対して抑制的に働く。 |
| e | RavulizumabはC3阻害薬である。 |
問題4.
ANCA関連血管炎と抗C5a 拮抗薬に関する次の記述のうち,誤った選択肢の組み合わせを1つ選べ。
1.ANCA関連糸球体腎炎の病理所見として間質の炎症は認めない。
2.ANCA関連血管炎では補体系の古典経路が関与する。
3.C5aは強力な好中球遊走因子である。
4.ANCA関連血管炎の標準寛解導入治療は,グルココルチコイドと免疫抑制薬の併用である。
5.抗C5a拮抗薬を使用すればグルココルチコイドなしで寛解導入可能である。
| a | (1.2.3) |
| b | (1.2.5) |
| c | (1.4.5) |
| d | (2.3.4) |
| e | (3.4.5) |
問題5.
M蛋白関連C3腎症に関する次の記述のうち,誤りはどれか。誤りを1 つ選べ。
| a | 意義不明の腎症を伴う単クローン性免疫グロブリン血症(MGRS)は,悪性腫瘍の診断基準は満たさないものの,モノクローナル免疫グロブリンが原因で腎臓に臓器障害が起きている状態である。 |
| b | MGRSの正確な診断には腎生検が不可欠であり,血清・尿の電気泳動や遊離軽鎖分析,骨髄生検などと併せて総合的に評価する。 |
| c | MGRSでは,単クローン性免疫グロブリンが,腎臓に沈着したり,結晶化したり,補体経路を活性化したりすることで腎障害を引き起こす。 |
| d | M蛋白関連C3腎症では,腎組織の免疫染色で糸球体に免疫グロブリンの強陽性を認める。 |
| e | M蛋白関連C3腎症の一部の症例では,通常の検査では見逃される「マスクされたモノクローナル沈着」を伴う場合があり,正確な診断のためには,プロテアーゼ消化処理による免疫染色が必要になることがある。 |
問題6.
次の抗補体薬の開発に関する記述のうち正しい組み合わせはどれか。正しい組み合わせを1つ選べ。
1.古典経路は生体内で常時活性化されている。
2.第二経路は補体経路の活性化の大部分を担う。
3.抗補体薬で治療中の患者は4価の髄膜炎菌ワクチンの接種後も,侵襲性髄膜炎菌感染症のリスクがある。
4.C3を抑制する作用がある抗補体薬の投与開始前に4価髄膜炎菌ワクチンを接種する。
5.抗C5モノクローナル抗体で治療中の患者は侵襲性髄膜炎菌感染症のリスクが約100倍になる。
| a | (1.2.3) |
| b | (1.2.5) |
| c | (1.4.5) |
| d | (2.3.4) |
| e | (3.4.5.) |
28歳男性。蛋白尿と多数の尿中赤血球を認め,血清Cr 1.80mg/dLであった。腎生検の結果,糸球体血管基底膜の菲薄化やlamination(層化)を認め,免疫染色にてIgA沈着は陰性であった。軽度の難聴を自覚している。58歳の母親は尿蛋白2+尿潜血3+,血清Cr 0.92mg/dLであった。この家系でみられる症状が同一遺伝子変異に起因するとき,この男性に女児が生まれた場合に本症が遺伝する確率を次から選べ。
| a | 0% |
| b | 25% |
| c | 50% |
| d | 75% |
| e | 100% |
問題2.
Alport症候群に関する次の記述のうち,誤りはどれか。1つ選べ。
| a | 近年はナトリウム・グルコース共輸送体2(sodium-glucose cotransporter 2:SGLT2)阻害薬などの有効性も検討されている。 |
| b | X染色体連鎖型Alport症候群の男性患者では,遺伝子型がレニン-アンジオテンシン系(renin-angiotensin system:RAS)阻害薬による治療効果に影響を及ぼす可能性がある。 |
| c | 最近の研究により,未診断の常染色体顕性Alport症候群患者が多数存在する可能性が示されている。 |
| d | 遺伝形式にかかわらず,診断がついたら速やかにレニン-アンジオテンシン系阻害薬を開始することが推奨されている。 |
| e | 疾患特異的治療として,ナンセンスリードスルーやエクソンスキッピング,遺伝子補充・編集治療などが研究されている。 |
問題3.
Fabry病に関する次の記述のうち,正しいものはどれか。2つ選べ。
| a | X連鎖遺伝形式であるが,女性ヘテロ患者も男性と同じ年代や重症度で発症する。 |
| b | 男性患者と女性患者とも白血球αガラクトシダーゼA活性の低下により診断される。 |
| c | 酵素補充療法は,進行した臓器病変には効果が乏しくなる。 |
| d | Fabry病に対する薬理学的シャペロン療法の適応は,GLA遺伝子解析の結果で判断する。 |
| e | Fabry病に起因する腎不全に対する腎移植では,個体生存率は他の原因による腎不全に対する腎移植より低い。 |
問題4.
遺伝性ネフローゼ症候群について正しい組み合せはどれか。1つ選べ。
1.遺伝性ネフローゼ症候群の多くは,ポドサイトの機能や構造に関連する遺伝子の異常に起因する。
2.先天性ネフローゼ症候群では約30%で何らかの遺伝子異常が同定される。
3.INF2遺伝子やTRPC6遺伝子の異常は常染色体潜性遺伝形式の巣状分節性糸球体硬化症の原因となる。
4.WT1遺伝子の異常は,Denys-Drash症候群やFrasier症候群と関連し,性分化異常を来すことがある。
5.コエンザイムQ10(CoQ10)生合成に関わる遺伝子(COQ2,COQ6,COQ8B など)の異常による蛋白尿では,CoQ10の補充療法が有効な場合がある。
| a | (1.2.3) |
| b | (1.2.5) |
| c | (1.4.5) |
| d | (2.3.4) |
| e | (3.4.5) |
問題5.
腎性尿崩症に関する次の記述のうち,誤りはどれか。2つ選べ。
| a | 本症患者における慢性腎臓病の発症率は,一般人口と変わらない。 |
| b | 水制限試験は,中枢性尿崩症と腎性尿崩症を区別するために行う検査である。 |
| c | バソプレシンの代替バイオマーカーとして期待されるコペプチンは,腎性尿崩症の患者で高値となる。 |
| d | バソプレシンV2受容体遺伝子の病的バリアントの中で,最も多いのはミスセンス変異で,蛋白の折りたたみ異常やシグナル伝達の異常を引き起こす。 |
| e | 折りたたみ異常を有するバソプレシンV2受容体蛋白の一部の変異体に対して,トルバプタンが薬理学的シャペロンとして機能する。 |
問題6.
家族歴のない成人の多発性囊胞腎(PKD)患者の診療手順に関する次の記述のうち正しいものはどれか。2つ選べ。
| a | 全例に対して遺伝学的検査を行う。 |
| b | 腹部超音波検査やCT・MRI 検査を行い,典型的な常染色体顕性多発性囊胞腎(ADPKD)の画像所見かを確認する。 |
| c | 家族歴がなければADPKDの可能性は低いので精査は不要である。 |
| d | 家族歴がなければトルバプタンの適応にはならない。 |
| e | 両親の病歴を再度確認し,可能であれば両親に腎囊胞がないか,腹部超音波検査などの画像検査を行う。 |